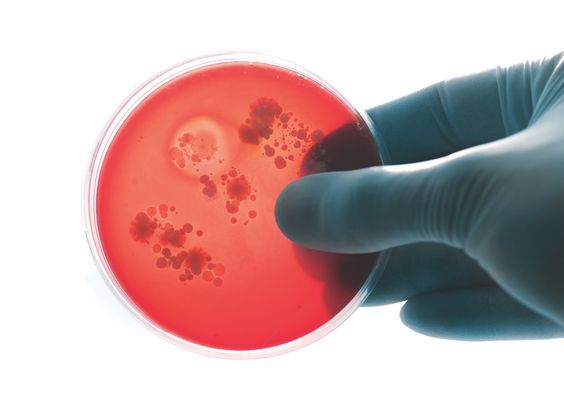

Conditions
Comprehensive Guide to Diabetes Management
Introduction
Diabetes is a chronic condition affecting millions worldwide, impacting how the body regulates blood sugar. This comprehensive guide provides valuable insights into diabetes management, empowering individuals to live healthier lives.

We'll delve into the different types of diabetes, explore the causes and symptoms, and discuss various aspects of diabetes …
Debunking Heart Disease Myths
Introduction
Heart disease remains a leading cause of death worldwide, impacting millions of lives. While medical advancements have improved diagnosis and treatment, many myths and misconceptions still surround this complex condition. These misunderstandings can lead to fear, misinformation, and potentially harmful decisions regarding heart health.

This article aims to debunk …
Angina Symptoms: When to Seek Help
Introduction:
Angina, also known as angina pectoris, is a concerning symptom often described as chest pain, pressure, or squeezing. It occurs when the heart muscle doesn't receive enough oxygen-rich blood, typically due to narrowed or blocked arteries. While angina itself isn't a heart attack, it serves as a warning sign …
Understanding Heart Palpitations
Introduction
Heart palpitations are a common experience characterized by a fluttering or pounding sensation in the chest. While often harmless, they can sometimes indicate an underlying medical condition. Understanding the causes, symptoms, and when to seek medical attention is crucial for managing heart palpitations effectively.

This article will delve into …
Heart Disease in Children: Recognizing Signs
Introduction
Heart disease doesn't just affect adults. While it's less common in children, it's crucial to be aware of the signs and symptoms. Early detection and treatment of heart conditions in children can significantly improve outcomes and quality of life.

This comprehensive guide will equip parents and caregivers with the …
Aging and Heart Health: Staying Healthy
Introduction
As we age, our bodies naturally undergo various changes, and our cardiovascular system is no exception. The heart, responsible for pumping blood throughout our bodies, can experience age-related changes that might increase the risk of heart disease. However, aging doesn't necessarily have to equate to declining heart health. By …
Men and Heart Disease: What to Know
Introduction
Heart disease is a serious health concern affecting millions of people worldwide. It's a leading cause of death for both men and women, but it often affects men differently. While heart disease can strike anyone, men are at a higher risk and tend to develop it earlier in life …
Women and Heart Disease: Unique Concerns
Introduction
Heart disease is often perceived as a predominantly male health issue. However, it's the leading cause of death for women in the United States, claiming more lives than all forms of cancer combined. While heart disease affects both genders, women often experience it differently than men. They may have …
The Role of Triglycerides in Heart Health
Introduction:
Triglycerides are a type of fat found in your blood. They are essential for energy storage and transport throughout the body. However, elevated triglyceride levels are a significant risk factor for heart disease, often working in tandem with other lipid abnormalities like high cholesterol.

This article delves into the …
Understanding Your Cholesterol Levels
Introduction
Cholesterol often gets a bad rap, but it's a crucial substance that our bodies need to function correctly. It's a fatty substance found in our blood and every cell in our body. Our liver produces the cholesterol we need, but we also get it from the foods we eat …
Identifying Heart Disease Risk Factors
Introduction
Heart disease remains a leading cause of death worldwide, emphasizing the importance of understanding and addressing its risk factors. While some factors are beyond our control, such as family history and age, others are modifiable, offering opportunities for prevention and management.

This blog post delves into the various risk …
Family History and Heart Disease Risk

Introduction:
Heart disease remains a leading cause of death worldwide, and understanding the risk factors associated with it is crucial for prevention and early intervention. While lifestyle choices significantly impact heart health, family history plays an undeniable role. This article delves into the connection between family history and heart disease …
The Link Between Obesity and Heart Health
Introduction
Obesity has become a global health concern, affecting millions of people worldwide. It is a complex condition characterized by an excessive accumulation of body fat, which can have serious implications for overall health, particularly for the cardiovascular system. The link between obesity and heart health is well-established, with obesity …
Diabetes and Its Impact on Heart Disease

Introduction:
Diabetes and heart disease are two serious health conditions that often go hand-in-hand. Diabetes, a metabolic disorder characterized by high blood sugar levels, significantly increases the risk of developing cardiovascular problems. This connection stems from the damage that prolonged high blood sugar inflicts on blood vessels and nerves, including …
Coronary Artery Disease: Causes and Treatments
Introduction
Coronary artery disease (CAD), also known as coronary heart disease, is a prevalent cardiovascular condition affecting millions worldwide. It occurs when the coronary arteries, responsible for supplying oxygen-rich blood to the heart muscle, become narrowed or blocked. This narrowing is primarily caused by the buildup of plaque, a sticky …
Understanding Atrial Fibrillation
Introduction
Atrial fibrillation (AFib) is a common heart rhythm disorder that affects millions of people worldwide. It occurs when the heart's upper chambers (atria) beat irregularly and rapidly, leading to inefficient blood flow. This can result in a range of symptoms, from mild discomfort to serious complications like stroke.

Understanding …
Stroke Prevention: Key Measures to Take

Introduction: A stroke, often referred to as a "brain attack," occurs when blood flow to a part of the brain is interrupted, depriving brain cells of oxygen and nutrients. This can lead to brain cell death and potentially long-term disabilities. Strokes are a leading cause of death and disability worldwide …
Heart Attack Warning Signs: What to Watch For
Introduction
A heart attack is a serious medical emergency that occurs when blood flow to the heart is blocked. This blockage can damage or destroy part of the heart muscle. Heart attacks are a leading cause of death for both men and women, so it's crucial to be aware of …
Recognizing Symptoms of Heart Disease
Introduction
Heart disease is a prevalent health concern affecting millions globally. Recognizing its symptoms early is crucial for timely intervention and improved outcomes. This comprehensive guide delves into the various indicators of heart disease, empowering individuals to take charge of their cardiovascular well-being.

Understanding the intricacies of heart disease symptoms …
Managing High Blood Pressure: Tips and Techniques
Introduction
High blood pressure, also known as hypertension, is a common condition that affects millions of people worldwide. It is often called a "silent killer" because it typically doesn't cause noticeable symptoms but can lead to serious health problems if left unmanaged. High blood pressure occurs when the force of …
Heart Disease Prevention: Top Strategies
Introduction
Heart disease remains a leading cause of death worldwide, but the good news is that many cases are preventable. By adopting a heart-healthy lifestyle, you can significantly reduce your risk of developing this serious condition.

This comprehensive guide will provide you with evidence-based strategies for preventing heart disease. We'll …
Comprehensive Guide to Cardiovascular Health
Introduction
Cardiovascular health is more than just the absence of disease; it's a state of optimal well-being that allows you to live your life to the fullest. This comprehensive guide will delve into the intricacies of cardiovascular health, providing you with the knowledge and tools to keep your heart healthy …
Insurance Considerations for Chronic Illness Management
Introduction
Managing a chronic illness presents a unique set of challenges, and navigating the complexities of health insurance can feel like an added burden. Understanding your insurance coverage is crucial to effectively manage your condition without facing overwhelming medical expenses. This comprehensive guide will provide valuable insights into insurance considerations …
Travel Tips for Those with Chronic Illness
Introduction
Traveling can be an enriching experience, offering opportunities to explore new places, cultures, and cuisines. However, for individuals living with chronic illnesses, the prospect of travel can often feel daunting. The key to enjoyable travel with a chronic condition lies in careful planning and preparation.

This comprehensive guide is …
Emergency Preparedness for Chronic Illness Patients
Introduction
Living with a chronic illness requires a different level of preparedness, especially when it comes to emergencies. Natural disasters, power outages, or even personal emergencies can significantly impact individuals with chronic health conditions. The need for medications, specialized equipment, and consistent care adds another layer of complexity to emergency …
Aging with Chronic Illness: Adapting to Changes
Introduction
Aging is a natural process we all experience, bringing with it a new chapter filled with unique challenges and triumphs. However, when you're aging with a chronic illness, this journey can present additional complexities. The experience of aging is intertwined with the management of a chronic condition, requiring ongoing …
Managing Chronic Illness in Children

Introduction:
Navigating the challenges of a chronic illness diagnosis in a child can be overwhelming for any parent or caregiver. The journey is often fraught with emotional, physical, and financial burdens. However, knowledge is power, and understanding how to best support your child can make a world of difference. This …
Managing Multiple Chronic Conditions
Introduction
Living with one chronic health condition can be challenging, but navigating life with two or more can feel overwhelming. Multiple chronic conditions, also known as multimorbidity, require careful attention to medication management, lifestyle adjustments, and coordination of care among different healthcare providers.

This post aims to provide guidance and …
Energy Conservation Techniques for Chronic Illness
Introduction
Living with a chronic illness often means navigating a delicate balance between daily activities and managing symptoms like fatigue, pain, and brain fog. Energy conservation is a key strategy that can help individuals maintain their independence, engage in meaningful activities, and improve their overall quality of life.

This article …
Monitoring Your Chronic Illness: Tools and Techniques
Introduction:
Living with a chronic illness often involves actively participating in your own care. This includes monitoring your condition to track symptoms, identify triggers, and manage your overall health. By taking a proactive approach to monitoring, you can gain valuable insights into your body's patterns and work collaboratively with your …
Caregiving for Chronic Illness: What You Need to Know
Introduction
Caring for a loved one with a chronic illness is a challenging but rewarding act of love. It requires immense emotional strength, physical endurance, and a deep well of patience. Whether you're new to caregiving or have been on this journey for a while, understanding the complexities of chronic …
Understanding Your Chronic Illness: Education is Key
Introduction:

A chronic illness diagnosis can feel overwhelming, often bringing a mix of emotions like fear, confusion, and uncertainty. It disrupts your life, impacting your daily routine, work, and relationships. But remember, knowledge is power. Understanding your condition is the first step towards reclaiming control and living a full life …
Coping with Fatigue: Energy Conservation Tips
Introduction
Fatigue, a pervasive feeling of tiredness or exhaustion, can significantly impact daily life, affecting our ability to work, socialize, and engage in enjoyable activities. While rest is crucial, sometimes even after a good night's sleep, fatigue persists. This is where energy conservation techniques come into play.

Energy conservation is …
Understanding Autoimmune Diseases
Introduction
Autoimmune diseases are a complex group of conditions that occur when the body's immune system, which normally protects against foreign invaders like bacteria and viruses, mistakenly attacks its own tissues. This can lead to a wide range of symptoms and affect various organs in the body.

While the exact …
Living with Chronic Illness: Tips for Everyday Life
Introduction
Living with a chronic illness can be challenging, impacting every aspect of daily life. From managing symptoms and treatments to navigating work, relationships, and self-care, it requires ongoing adaptation and resilience. The unpredictable nature of many chronic illnesses adds another layer of complexity, making it difficult to plan and …
Common Sleep Disorders and Their Impact
Introduction
A good night's sleep is crucial for our physical and mental health. However, millions of people struggle with sleep disorders that can significantly impact their daily lives. Sleep disorders involve problems with the quality, timing, or amount of sleep, leading to daytime distress and impairment.

This blog post will …
Understanding Sleep Apnea: Symptoms and Treatments
Introduction:
Sleep apnea is a common sleep disorder that affects millions of people worldwide. It is characterized by pauses in breathing or shallow breaths during sleep. These pauses can last from a few seconds to minutes and can occur multiple times throughout the night. Sleep apnea disrupts sleep and can …
Effective Chronic Illness Management Strategies
Introduction
Living with a chronic illness can be challenging, impacting various aspects of daily life. However, adopting effective management strategies can empower individuals to take control of their health and enhance their overall well-being.

This article delves into practical tips and evidence-based advice to help individuals navigate the complexities of …
Sleep Deprivation: Signs, Causes, and Solutions
Introduction
Sleep is an essential human need, just like eating, drinking, and breathing. It allows our bodies and minds to rest, repair, and rejuvenate. When we consistently don't get enough sleep, we experience sleep deprivation, which can significantly impact our physical and mental health, mood, and overall well-being.

Sleep deprivation …
How to avoid fatty liver
How to avoid fatty liver
Fatty liver disease (FLD) is a condition in which excess fat builds up in the liver. It is a common condition, affecting up to 30% of adults worldwide. There are two main types of FLD:
Non-alcoholic fatty liver disease (NAFLD): This is the most common …
Understanding UV-Induced Skin Aging
Understanding UV-Induced Skin Aging
Most of us cherish those warm, sunny days, soaking up the sun's rays. However, beneath that golden glow lies a less glamorous reality: UV-induced skin aging. While we all associate a tan with good health, prolonged sun exposure can significantly impact our skin's health and appearance …
Preventing and Treating Insect Bites
Introduction:
As the weather warms and we venture outdoors to enjoy the sunshine, we inevitably encounter insects. While most are harmless, some can leave us with itchy, uncomfortable bites. Knowing how to prevent and treat insect bites can help you enjoy the outdoors with peace of mind.

Insect bites are …
Understanding Sun-Induced Hyperpigmentation
Introduction
Have you ever noticed dark spots appearing on your skin, especially after spending time in the sun? You might be experiencing hyperpigmentation, a common skin condition that affects people of all ages and skin tones. Hyperpigmentation occurs when the skin produces excess melanin, the pigment responsible for our skin …
Identifying Symptoms of Heat Edema
Introduction:
Heat edema is a temporary condition that causes swelling in your extremities, typically during hot weather. It is the body’s response to unusual heat and often affects people who are not used to warmer temperatures. As your body attempts to cool itself in the heat, your blood vessels …
Treating Sunburn-Induced Peeling
Introduction:
Ah, summertime. The warm sun, the cool breeze, and the dreaded sunburn. We’ve all been there. Despite our best efforts to slather on sunscreen, sometimes those pesky UV rays still manage to sneak through, leaving us with a painful reminder of our fun in the sun. One of …
Skin Conditions Caused by UV Exposure
Introduction
The sun's ultraviolet (UV) radiation is the primary cause of skin cancer, but did you know that it can also cause a range of other skin conditions? UV radiation damages your skin cells' DNA, leading to various issues, from premature aging to more severe health concerns.

This article will …
Recognizing Heat Exhaustion in Kids
Introduction:
Summer is a time for kids to enjoy the outdoors, from splashing in pools to building sandcastles on the beach. But with the joy of warm weather comes the risk of heat-related illnesses, particularly for our little ones. Heat exhaustion, a serious condition caused by prolonged exposure to high …
Recognizing and Treating Heat Syncope
Introduction:
Heat syncope, also known as fainting from heat, is a temporary loss of consciousness that occurs due to overheating. It's typically triggered by prolonged exposure to high temperatures, especially when combined with dehydration and physical exertion. When your body overheats, your blood vessels dilate to allow more blood to …
Preventing Heat Cramps During Exercise
Introduction:
Heat cramps are a common and painful ailment that can strike anyone, especially during strenuous physical activity in hot weather. They are caused by a depletion of electrolytes like sodium and potassium, which are essential for muscle function. When we sweat, we lose these electrolytes, and if they are …
Managing Seasonal Flu Symptoms
Introduction:
The changing seasons often bring about more than just a shift in weather; they can also usher in the dreaded flu season. Seasonal flu, commonly known as the flu, is a respiratory illness caused by influenza viruses. It's characterized by a range of symptoms, including fever, cough, sore throat …
Managing Sunburn: Tips and Remedies
Introduction:
Sunburn. We've all been there – the telltale pink (or worse, crimson) hue that screams a day spent basking a little too much in the sun's warm embrace. It's a painful reminder of the importance of sun protection, often accompanied by stinging skin, redness, and that dreaded tight feeling. But …
Heat-Induced Fainting: What to Do
Introduction:
Heat-induced fainting, also known as heat syncope, is a sudden loss of consciousness that occurs due to exposure to high temperatures. It happens when the body's heat-regulating mechanisms are overwhelmed, leading to a drop in blood pressure. This drop in blood pressure reduces blood flow to the brain, resulting …
Understanding UV Radiation and Skin Safety
Introduction
Summer is synonymous with sunshine, but with the sun's warm rays comes an invisible threat to our skin: ultraviolet (UV) radiation. This type of radiation, while essential for vitamin D production, can pose significant risks if we don't take proper precautions. Understanding UV radiation and its potential impact on …
Identifying Heat Exhaustion Symptoms
Introduction
As temperatures rise during the summer months, it's crucial to be aware of the dangers of heat exhaustion. Heat exhaustion is a heat-related illness that can occur after prolonged exposure to high temperatures, especially when accompanied by dehydration. Recognizing the symptoms of heat exhaustion is vital for early intervention …
Understanding Sun-Induced Blisters
Introduction
Sun-induced blisters, often referred to as sun blisters or sun poisoning, are a painful skin reaction caused by prolonged exposure to ultraviolet (UV) radiation from the sun. They manifest as fluid-filled sacs on the skin's surface, typically appearing red, inflamed, and tender to the touch. While anyone can experience …
Recognizing Dehydration Symptoms
Introduction
Dehydration occurs when your body loses more fluids than it takes in, leading to an imbalance in electrolytes. It's crucial to recognize the signs of dehydration early on, as it can affect anyone, regardless of age or health status. While common during hot weather or after strenuous exercise, dehydration …
Sun Allergy: What You Need to Know
Introduction:
For some, the arrival of sunshine brings with it the itchy misery of sun allergy. This condition, medically known as polymorphic light eruption (PMLE), is an abnormal immune system reaction to sunlight. While the exact causes of sun allergy aren't fully understood, it's thought to be triggered by changes …
Managing Psoriasis in Hot Weather
Introduction:
Summer's arrival brings the promise of sunshine and outdoor activities. But for many of those living with psoriasis, the heat and humidity can trigger uncomfortable flare-ups. Psoriasis is a chronic autoimmune disease that causes skin cells to multiply rapidly, leading to itchy, scaly patches. While there's no one-size-fits-all solution …
Allergy Management During Hot Weather
Introduction:
Summer's warmth brings sunshine, outdoor activities, and unfortunately, allergy flare-ups for many. As temperatures rise, so do pollen counts, mold spores thrive in humidity, and insects become more active. All these factors can trigger a wave of discomfort for allergy sufferers, turning sunny days into sneezy, itchy ordeals.

Managing …
Heat Stroke: Prevention and Care
Introduction
As temperatures rise during the summer months, it's crucial to be aware of the dangers of heat stroke. Heat stroke is a severe heat-related illness that occurs when the body's temperature regulation system fails, and it can be life-threatening. Understanding the causes, symptoms, prevention methods, and first-aid measures for …
Sun Poisoning: Symptoms and Treatment
Introduction:
Sun poisoning, a severe form of sunburn, occurs after prolonged or intense exposure to ultraviolet (UV) radiation from the sun. It's crucial to understand that sun poisoning is essentially a more serious degree of sunburn, not a distinct condition. This means that while all cases of sun poisoning involve …
Heat-Induced Urticaria: Managing Symptoms
Introduction:
Heat urticaria is a rare skin condition that manifests as itchy red welts or hives on the skin after exposure to heat. This can occur from various sources like hot showers, exercise, or even warm weather. While it's not a life-threatening condition, the symptoms can be uncomfortable and disruptive …
Preventing Sun-Induced Migraines
Introduction:
For many, the arrival of sunshine signals long-awaited days of warmth and outdoor activities. But for others, the sun's intense rays can trigger a debilitating health issue: migraines. Sun-induced migraines, also known as photophobic migraines, are a subtype of migraine characterized by intense head pain often accompanied by nausea …
Managing Eczema in Hot Weather
Introduction:
Summer's warmth is often a welcome change, but for those with eczema, it can usher in a wave of unique challenges. Hot, humid weather can trigger flare-ups, making already sensitive skin even more itchy and uncomfortable. The good news is that with proactive skincare and lifestyle adjustments, you can …
Managing Heat Sensitivity
Managing Heat Sensitivity
Living with heat sensitivity can be challenging, especially during warmer months. Whether you're prone to heat exhaustion, experience discomfort in hot weather, or have an underlying medical condition that makes you more susceptible to heat, there are ways to effectively manage heat sensitivity and maintain your comfort …
Dealing with Photodermatitis
Introduction
Photodermatitis, sometimes called "sun allergy" or "sun poisoning," is an uncomfortable skin reaction triggered by sun exposure. It's more complex than a typical sunburn and can manifest in various ways, from itchy rashes and blisters to scaly patches and raised welts. Understanding photodermatitis is the first step towards protecting …
Dealing with Prickly Heat Rash
Introduction:
Prickly heat, also known as heat rash, is a common skin condition that occurs when sweat ducts become blocked, trapping perspiration under the skin. This can lead to small, itchy, and often prickly bumps or blisters. While it can affect anyone, prickly heat is particularly common in infants and …
Heat-Related Eye Conditions: Prevention
Introduction:
Summer is a time for fun in the sun, but it's important to be aware of the dangers that heat can pose to our health, including our eyes. Heat-related eye conditions can range from mild and temporary to serious and sight-threatening.

Just as prolonged sun exposure can damage our …
Heat-Related Illnesses: Prevention and Care
Introduction
As temperatures rise during the summer months, it's crucial to be aware of the dangers of heat-related illnesses. These illnesses, ranging from mild heat cramps to life-threatening heatstroke, occur when the body's temperature regulation system is overwhelmed by excessive heat. Understanding the risks, recognizing the symptoms, and taking preventive …
Common Skin Conditions from Sun Exposure
Introduction
The sun is a powerful source of energy that provides us with essential vitamin D and can boost our mood. However, excessive sun exposure can have detrimental effects on our skin, leading to a range of skin conditions. Understanding the risks and taking preventative measures is crucial for maintaining …
Preventing and Treating Heat Rash
Introduction:
Heat rash, also known as prickly heat or miliaria, is a common skin condition that occurs when sweat glands are blocked, trapping perspiration under the skin. This can lead to small, itchy, and often uncomfortable bumps or blisters. Heat rash is particularly prevalent in hot, humid weather, affecting people …
Managing Seasonal Allergies Effectively
Introduction
For millions, the arrival of spring brings with it more than just blooming flowers and warmer weather—it also ushers in the dreaded allergy season. Seasonal allergies, often triggered by pollen released from trees, grasses, and weeds, can cause a range of uncomfortable symptoms, from sneezing and runny noses …
Dealing with Seasonal Asthma
Introduction
As the seasons change, many individuals experience the joy of blooming flowers, warm sunshine, and crisp autumn air. However, for those with seasonal asthma, these transitions can bring about a wave of respiratory challenges. Seasonal asthma, also known as allergic asthma, is triggered by specific allergens prevalent during certain …
Skin Reactions to Sun Exposure
Introduction
The sun is a powerful source of energy that sustains life on Earth. However, the ultraviolet (UV) radiation in sunlight can also have damaging effects on our skin. While most people associate sun exposure with sunburns, there are actually a wide range of skin reactions that can occur due …
ADHD Treatment Options
Introduction:
Attention-Deficit/Hyperactivity Disorder (ADHD) is a neurodevelopmental disorder that presents itself in childhood and can continue into adulthood. It affects millions of people around the world. Symptoms include inattentiveness, hyperactivity, and impulsivity, which can significantly impair daily life, work, and relationships. The good news is that ADHD is manageable …
Bipolar Disorder Therapy
Introduction
Bipolar disorder, formerly known as manic depression, is a mental health condition that causes extreme mood swings that include emotional highs (mania or hypomania) and lows (depression). These mood swings can affect sleep, energy, activity levels, judgment, behavior, and the ability to think clearly.

Living with bipolar disorder can …
Living with Fibromyalgia
Introduction:
Living with fibromyalgia can feel like an uphill battle. It's a chronic condition that causes widespread musculoskeletal pain, fatigue, and other debilitating symptoms like sleep problems, mood disorders, and cognitive dysfunction (also known as "fibro fog"). This invisible illness is often misunderstood, making it difficult for individuals to receive …
Gout Treatment Tips
Introduction:
Gout is a painful inflammatory condition that affects the joints, often causing sudden and intense pain, swelling, and redness. It occurs when there's a buildup of uric acid in the blood, leading to the formation of sharp urate crystals in the joints. While genetics play a role, lifestyle choices …
Living with Autoimmune Conditions
Living with Autoimmune Conditions
Living with an autoimmune condition can be challenging, often requiring significant adjustments to daily life. These conditions arise when the body's immune system mistakenly attacks its own healthy cells and tissues. This can manifest in a wide range of symptoms, impacting various parts of the body …
Hepatitis C Management Tips
Introduction:
Hepatitis C is a viral infection that affects the liver, often leading to inflammation. This condition is caused by the hepatitis C virus (HCV). While some people experience mild symptoms or none at all, others can develop chronic hepatitis C, leading to severe liver damage, cirrhosis, or even liver …
Scoliosis Exercises for Pain Relief
Introduction
Scoliosis is a condition that causes an abnormal curvature of the spine. It can occur at any age, but it is most commonly diagnosed in adolescents. Scoliosis can cause pain, stiffness, and fatigue, and it can also make it difficult to breathe and participate in certain activities.

While there …
Lyme Disease Treatment Options
Introduction
Lyme disease, a tick-borne illness caused by the bacterium Borrelia burgdorferi, presents a growing concern for outdoor enthusiasts and residents of endemic areas. Early diagnosis and treatment are crucial for preventing potentially debilitating long-term complications. This article delves into the various Lyme disease treatment options available, offering a comprehensive …
Dementia Care Strategies
Introduction
Dementia is a challenging condition that affects millions of people worldwide, placing a significant emotional, physical, and mental strain on both individuals living with dementia and their caregivers. As the condition progresses, it impacts cognitive abilities, memory, and behavior, leading to a range of complex needs that require specialized …
Managing Asthma Effectively
Introduction:
Asthma is a chronic respiratory condition that affects millions of people worldwide. It is characterized by inflammation and narrowing of the airways, which can make it difficult to breathe. Symptoms of asthma can range from mild to severe and may include wheezing, coughing, shortness of breath, and chest tightness …
Managing Type 2 Diabetes
Introduction
Living with type 2 diabetes requires ongoing management and attention to various aspects of your health and well-being. This chronic condition affects how your body regulates blood sugar, and without proper care, it can lead to a range of complications. However, by understanding the condition and implementing effective management …
Multiple Sclerosis Treatment Options
Introduction:
Multiple sclerosis (MS) is a chronic, unpredictable disease that affects the central nervous system, which comprises the brain, spinal cord, and optic nerves. It occurs when the immune system mistakenly attacks the myelin, a fatty substance that insulates and protects nerve fibers. This damage disrupts the flow of information …
Understanding Alzheimers Disease
Understanding Alzheimer’s Disease
Alzheimer's disease is a progressive brain disorder that slowly destroys memory and thinking skills, and eventually, the ability to carry out the simplest tasks. It is the most common cause of dementia — a continuous decline in thinking, behavioral and social skills that disrupts a person's ability …
Sickle Cell Disease: What You Need to Know
Introduction:
Sickle cell disease is a group of inherited red blood cell disorders. Red blood cells are typically round and flexible, which allows them to move easily through blood vessels. In sickle cell disease, these cells become hard and sticky and resemble a C-shaped farm tool called a “sickle”. The …
Understanding HIV Treatment
Introduction
Living with HIV might seem daunting at first, but understanding available treatments can empower individuals to live full and healthy lives. HIV (human immunodeficiency virus) attacks the body’s immune system, making it difficult to fight off infections. Thankfully, advancements in medicine have led to effective treatments that allow …
COPD Management Tips
Introduction
Chronic obstructive pulmonary disease (COPD) is a chronic lung disease that makes it hard to breathe. It is the third leading cause of death in the United States, according to the American Lung Association. COPD is characterized by airflow obstruction that makes it difficult to exhale normally. This is …
Treating Ulcerative Colitis
Introduction:
Ulcerative colitis (UC) is a chronic, inflammatory bowel disease (IBD) that affects the lining of the large intestine (colon) and rectum. This condition causes inflammation and ulcers to develop, leading to a range of uncomfortable and often debilitating symptoms. Individuals with UC experience periods of active disease, known as …
Treating Eczema Naturally: A Guide
Introduction:
Eczema, also known as atopic dermatitis, is a chronic skin condition that causes dry, itchy, and inflamed skin. It affects millions of people worldwide, and while there is no cure, several treatments can help manage the symptoms.

While conventional treatments like corticosteroids and antihistamines can be effective, many people …
IBS Management Tips
Introduction:
Irritable Bowel Syndrome (IBS) is a common disorder that affects the large intestine. It is a chronic condition that requires long-term management. Symptoms can vary from person to person and range from mild to severe. Common symptoms include cramping, abdominal pain, bloating, gas, diarrhea, and constipation.

While the exact …
Understanding Hypothyroidism
Introduction
Hypothyroidism, often referred to as an underactive thyroid, is a disorder that occurs when the thyroid gland doesn't produce enough thyroid hormone. The thyroid is a small, butterfly-shaped gland located in the front of your neck, responsible for regulating metabolism—the process by which your body uses energy. When …
Recognizing Tuberculosis Symptoms
Introduction:
Tuberculosis (TB) is a bacterial infection that primarily affects the lungs, but can also impact other parts of the body. It's a serious condition, but the good news is that it's treatable and curable, especially with early detection and proper medical care.

Understanding the symptoms of tuberculosis is crucial …
Diagnosing and Treating Sleep Apnea
Introduction
Sleep apnea is a common sleep disorder characterized by pauses in breathing or shallow breaths during sleep. These pauses can last from a few seconds to minutes and can occur multiple times per night. The most common type of sleep apnea is obstructive sleep apnea, in which the airway …
Understanding Hypertension
Introduction
Hypertension, commonly known as high blood pressure, is a prevalent condition affecting millions worldwide. It is often called a "silent killer" because it may not present noticeable symptoms for years, yet silently damages vital organs like the heart, kidneys, and brain.

This comprehensive guide aims to unravel the complexities …
Coping with Chronic Fatigue
Introduction
Chronic fatigue syndrome (CFS) is a debilitating and complex disorder characterized by persistent and overwhelming fatigue that is not relieved by rest. This fatigue can significantly impact daily life, making it challenging to carry out work, school, or social activities. The exact causes of CFS are still unknown, but …
Controlling Epilepsy: Tips and Tricks
Introduction:
Living with epilepsy can be challenging, but it doesn't have to control your life. By understanding your condition and working closely with your healthcare provider, you can take proactive steps towards better managing your seizures and improving your overall well-being. While there is no one-size-fits-all approach to epilepsy control …
Managing Chronic Migraines
Introduction:
Chronic migraines are a debilitating neurological condition characterized by frequent and severe headaches. These headaches typically last for four hours or more and can significantly impact an individual's quality of life. The pain associated with chronic migraines is often described as a throbbing or pulsating sensation on one or …
Heart Disease Treatment Options
Introduction:
Heart disease is a prevalent health concern affecting millions worldwide. It encompasses a range of conditions that impact the heart's structure and function, often leading to serious complications if left unaddressed. Fortunately, advancements in medical science have paved the way for numerous treatment options, offering hope and improved quality …
Relief for Endometriosis
Introduction:
Endometriosis is a common yet often misunderstood condition affecting millions of women worldwide. It occurs when tissue similar to the lining of the uterus (endometrium) grows outside of the uterus, commonly in the pelvic area. This misplaced tissue can cause a range of symptoms, from painful periods and heavy …
Diet for Crohn’s Disease
Introduction:
Crohn's disease is a chronic inflammatory bowel disease (IBD) that can affect any part of the digestive tract, from the mouth to the anus. It is characterized by inflammation, which can cause a variety of symptoms, including abdominal pain, diarrhea, weight loss, and fatigue.

While there is no cure …
Relief for Osteoarthritis Pain
Understanding Osteoarthritis and the Quest for Relief
Osteoarthritis is a prevalent condition affecting millions worldwide, causing pain, stiffness, and reduced mobility in joints. This degenerative disease occurs when the protective cartilage within joints wears down, leading to bone-on-bone friction. The result? A dull ache that can flare into intense pain …
Anxiety Treatment Options
Introduction:
Anxiety is a common mental health condition that affects millions of people worldwide. It is characterized by feelings of worry, nervousness, and fear that can interfere with daily life. While occasional anxiety is normal, excessive or persistent anxiety can be debilitating. The good news is that effective anxiety treatment …
Caring for Psoriasis
Understanding Psoriasis
Psoriasis is a chronic autoimmune condition that affects the skin. It occurs when the immune system mistakenly attacks healthy skin cells, causing them to multiply rapidly. This rapid cell turnover leads to the buildup of thick, scaly patches of skin called plaques. These plaques are often red, itchy …
Living with Lupus
Living with Lupus
Introduction
Living with lupus can be challenging, marked by unpredictable flares and a wide range of symptoms that impact daily life. This autoimmune disease occurs when the body's immune system attacks its own tissues and organs, leading to inflammation and damage. Understanding the complexities of lupus, including …
Understanding Anxiety Disorders
Introduction:
Anxiety is a normal human emotion that everyone experiences from time to time. It's that feeling of worry, nervousness, or unease that we all get when faced with a challenging situation, like a job interview or a big test. However, when anxiety becomes persistent, overwhelming, and begins to interfere …
Gout: Symptoms, Causes, and Treatment
Introduction:
Gout is a common and complex form of inflammatory arthritis that affects millions of people worldwide. It's characterized by sudden, severe attacks of pain, swelling, redness, and tenderness in the joints, often the joint at the base of the big toe. While gout can affect anyone, it's more common …
Psoriasis: Causes, Symptoms, and Treatment
Introduction:
Psoriasis is a chronic, autoimmune skin condition that affects millions of people worldwide. It is characterized by the rapid buildup of skin cells, leading to thick, scaly patches that can be itchy, painful, and even debilitating in severe cases. While there is no cure for psoriasis, various treatment options …
Managing Thyroid Disorders
Introduction
The thyroid, a small, butterfly-shaped gland located in the neck, plays a crucial role in regulating metabolism, energy levels, and overall health. Thyroid disorders occur when this gland produces too much or too little thyroid hormone, leading to a range of symptoms that can significantly impact daily life.

Millions …
Living with Multiple Sclerosis
Living with Multiple Sclerosis
Living with multiple sclerosis (MS) presents unique challenges, affecting individuals physically, emotionally, and mentally. This chronic autoimmune disease disrupts the central nervous system's ability to communicate effectively with the rest of the body. While the specific causes of MS remain unknown, its impact on daily life …
How to Manage Sleep Apnea
Introduction:
Sleep apnea is a common sleep disorder that affects millions of people worldwide. It is characterized by pauses in breathing or shallow breaths during sleep. These pauses can last from a few seconds to minutes and can occur multiple times per night. Sleep apnea disrupts sleep quality, leading to …
Hemorrhoids: Symptoms and Treatment
Introduction
Hemorrhoids, a common ailment that affects millions worldwide, often bring discomfort and embarrassment. These swollen veins in the rectum and anus can cause pain, itching, and bleeding, significantly impacting daily life. Understanding the causes, symptoms, and treatment options for hemorrhoids is crucial for effectively managing this condition.

This comprehensive …
Understanding Lupus: Symptoms and Management
Introduction:
Lupus is a chronic autoimmune disease that can affect various parts of the body. It occurs when the body's immune system attacks its own tissues and organs. This can cause inflammation and damage to the joints, skin, kidneys, heart, lungs, blood cells, and brain.

Lupus is a complex and …
Managing Diabetes: Tips and Tools
Introduction:
Living with diabetes requires careful management to maintain stable blood sugar levels and prevent complications. It involves a multifaceted approach encompassing diet, exercise, medication, and lifestyle modifications. While it can feel overwhelming at times, having the right tools and strategies in place can make managing diabetes much more manageable …
Living with Osteoarthritis
Living with Osteoarthritis
Osteoarthritis is a common condition that affects millions of people around the world. It is a degenerative joint disease that occurs when the cartilage that cushions the bones in your joints breaks down. This can cause pain, stiffness, and swelling in the affected joints. While there is …
Understanding and Treating Hepatitis C
Introduction
Hepatitis C is a viral infection that affects the liver, causing inflammation and potentially leading to serious liver damage. The Hepatitis C virus (HCV) is spread through contact with infected blood. Globally, millions of people live with Hepatitis C, often unaware due to its subtle symptoms.

While Hepatitis C …
Lyme Disease: Symptoms and Treatment
Introduction
Lyme disease, a tick-borne illness, presents a growing concern in many parts of the world. Caused by the bacterium Borrelia burgdorferi, Lyme disease is primarily transmitted to humans through the bite of infected blacklegged ticks. Early detection and treatment are crucial in managing the disease and preventing potentially debilitating …
Living with Endometriosis
Living with Endometriosis
Introduction
Endometriosis is a chronic condition that affects millions of women worldwide. It occurs when tissue similar to the lining of the uterus (the endometrium) grows outside of the uterus, most commonly in the pelvic area. This tissue behaves like the lining of the uterus, thickening, breaking …
Managing Menstrual Disorders
Introduction:
Menstrual disorders are a common health concern for women of all ages. They can cause a wide range of symptoms, from irregular periods to heavy bleeding and severe pain. While some menstrual irregularities are normal, others can indicate underlying medical conditions. Understanding the different types of menstrual disorders, their …
Understanding Tuberculosis
Understanding Tuberculosis
Tuberculosis (TB) is a bacterial infection that primarily affects the lungs, although it can impact other parts of the body as well. Caused by the bacterium Mycobacterium tuberculosis, TB spreads through the air when an infected person coughs, sneezes, or talks.

While TB is curable and preventable, it …
Managing Scoliosis: Tips and Treatments
Introduction:
Scoliosis, a condition characterized by a sideways curvature of the spine, affects millions of people worldwide. It often emerges during adolescence but can also occur in adults. While the thought of a spinal curvature can be daunting, understanding scoliosis and its management is the first step towards living a …
Effective Migraine Relief Strategies
Introduction:
Migraines are a debilitating neurological condition that affects millions of people worldwide. Characterized by intense, throbbing headaches, often accompanied by nausea, vomiting, and sensitivity to light and sound, migraines can significantly impact daily life. While there is no one-size-fits-all cure for migraines, several effective strategies can help individuals manage …
How to Manage High Cholesterol
Introduction:
High cholesterol is a common health concern that affects millions of people worldwide. It is a major risk factor for heart disease, which is the leading cause of death for both men and women.
Cholesterol is a fatty substance that is essential for the body to function properly. However …
Living with Irritable Bowel Syndrome
Introduction:
Irritable Bowel Syndrome (IBS) is a common disorder that affects the large intestine. It is a chronic condition that requires long-term management, but with the right approach, individuals with IBS can live full and active lives.
Symptoms of IBS can vary from person to person and range in severity …
Understanding Chronic Fatigue Syndrome
Introduction
Chronic Fatigue Syndrome (CFS), also known as Myalgic Encephalomyelitis (ME/CFS), is a complex and debilitating disorder characterized by persistent and overwhelming fatigue that is not relieved by rest. This fatigue can significantly impact daily life, making even simple tasks feel impossible. Individuals with ME/CFS often experience a …
Managing Parkinsons Disease
Introduction:
Parkinson's disease is a chronic and progressive neurological disorder that affects movement. It is characterized by tremors, stiffness, slowness of movement, and difficulty with balance and coordination. While there is no cure for Parkinson's disease, there are many things that can be done to manage the symptoms and improve …
Preventing Heart Disease: A Comprehensive Guide
Introduction:
Heart disease remains a leading cause of death worldwide, but the good news is that it's largely preventable. By understanding the risk factors and making lifestyle changes, you can significantly reduce your chances of developing this serious condition. This comprehensive guide will provide you with actionable steps to protect …
Living with Crohns Disease: Tips and Treatments
Introduction
Crohn's disease is a chronic inflammatory bowel disease (IBD) that affects the lining of the digestive tract. It can cause a variety of symptoms, including abdominal pain, diarrhea, weight loss, and fatigue. There is no cure for Crohn's disease, but there are treatments that can help manage the symptoms …
COPD: Symptoms, Treatment, and Management
Introduction
Chronic obstructive pulmonary disease (COPD) is a group of lung diseases that cause airflow blockage and breathing-related problems. It is a long-term condition that can significantly impact a person's quality of life. Millions of people worldwide live with COPD, and it is a leading cause of morbidity and mortality …
Glaucoma: Symptoms, Treatment, and Management
Introduction:
Glaucoma is a group of eye conditions that damage the optic nerve, which connects the eye to the brain. This nerve is vital for clear vision, and damage to it can lead to vision loss and blindness. The damage is often caused by abnormally high pressure in your eye …
Sickle Cell Anemia: Symptoms and Treatment
Introduction:
Sickle cell anemia is an inherited blood disorder that affects red blood cells. Red blood cells are responsible for carrying oxygen throughout the body. In sickle cell anemia, the red blood cells become misshapen and resemble a crescent or sickle, hence the name.

These abnormally shaped cells can block …
Eczema: Causes, Symptoms, and Treatment
Introduction:
Eczema, also known as atopic dermatitis, is a common skin condition that causes dry, itchy, and inflamed skin. It affects people of all ages but often begins in childhood. Eczema can be uncomfortable and distressing, but with proper management, individuals can alleviate symptoms and live full lives. This blog …
Managing Rheumatoid Arthritis Symptoms
Introduction
Rheumatoid arthritis (RA) is a chronic autoimmune disease that causes pain, stiffness, swelling, and limited motion and function in joints. RA is a systemic disease, which means it can affect the entire body and may cause problems in areas like the eyes, lungs, and skin. As many as 1 …
Dementia: Symptoms, Causes, and Treatment
Introduction:
Dementia is not a single disease but rather a general term used to describe a decline in cognitive function that affects daily life. This decline, which is greater than what would be expected from normal aging, can manifest in various ways, impacting memory, thinking, language, judgment, and behavior. It's …
Chronic Pain Management Strategies
Introduction:
Chronic pain, defined as persistent pain lasting for three months or longer, affects millions worldwide. This debilitating condition can significantly impact an individual's quality of life, interfering with daily activities, work, and mental well-being. Understanding the multidimensional nature of chronic pain is crucial for effective management. Unlike acute pain …
Melasma: Treatment, Causes and Prevention
Introduction
Melasma is a common skin condition that causes brown or gray-brown patches, usually on the face. It's more common in women, especially those with darker skin tones. While melasma is harmless, it can be frustrating for those who experience it.

The exact cause of melasma is unknown, but it's …
Muscle Strains: Causes, Symptoms, Treatment and FAQs
Introduction:
A muscle strain, often called a pulled muscle, occurs when muscle fibers stretch or tear due to overexertion or sudden force. This common injury can affect various muscles throughout the body, causing pain, limited range of motion, and difficulty performing everyday activities. Understanding the causes, symptoms, and treatment options …
Adenovirus: Symptoms, Causes and Treatment
Introduction
Adenoviruses are a group of common viruses that can cause a range of illnesses, from mild respiratory infections to more serious conditions like pneumonia and conjunctivitis. These viruses are highly contagious and can spread easily through the air and close contact.

While most adenovirus infections are mild and resolve …
Myopia, Nearsightedness: Causes, Symptoms and Treatment
Introduction:
Myopia, also known as nearsightedness, is a common vision condition where you can see objects clearly up close, but distant objects appear blurry. This happens when the shape of your eye causes light rays to focus incorrectly, projecting images in front of your retina instead of directly on it …
Cataracts: Signs, Symptoms and Treatment Options
Introduction
Cataracts are a common age-related eye condition that affects millions worldwide. It involves the clouding of the natural lens of the eye, which is normally clear. This clouding interferes with light passing through the lens to the retina, leading to vision impairment. While cataracts typically develop slowly and painlessly …
Thrush: Symptoms, Causes and Treatment
Introduction
Thrush, also known as oral candidiasis, is a fungal infection that develops in your mouth. It's caused by an overgrowth of the Candida albicans fungus, which is a common microorganism found in the body. While Candida is typically harmless, certain conditions can allow it to multiply and cause thrush …
Alzheimers Disease: Causes, Symptoms, Treatment and Stages
Introduction
Alzheimer's disease is a progressive neurodegenerative disorder that affects memory, thinking, and behavior. It is the most common cause of dementia, accounting for 60-80% of cases. The disease is characterized by the buildup of amyloid plaques and tau tangles in the brain, leading to the loss of neurons and …
Hyperpigmentation: Age Spots, Sun Spots and Liver Spots
Introduction
Hyperpigmentation is a common skin condition that causes patches of skin to become darker than the surrounding skin. It occurs when the skin produces too much melanin, the pigment that gives skin its color. Hyperpigmentation can be caused by a variety of factors, including sun exposure, hormonal changes, and …
Deviated Septum: What Is It, Causes, Treatment and Symptoms
Introduction
A deviated septum is a common condition in which the nasal septum, the thin wall that divides the nasal cavity in half, is off-center or crooked. This can lead to difficulty breathing through the nose, as well as other symptoms like nosebleeds, snoring, and facial pain.

A deviated septum …
Congestive Heart Failure: Symptoms, Stages and Treatment
Introduction
Congestive heart failure (CHF) is a serious condition that occurs when the heart can't pump enough blood to meet the body's needs. It's a chronic and progressive condition, meaning it develops over time and tends to worsen. While it can be a daunting diagnosis, understanding CHF is the first …
Smallpox: Causes, Symptoms, Treatment and Prevention
Introduction
Smallpox is an eradicated infectious disease caused by the variola virus. It was one of the most devastating diseases in human history, characterized by a high mortality rate and disfiguring scars in survivors. Thanks to a global vaccination effort, smallpox was declared eradicated in 1980, marking a significant triumph …
Abscess: Types, Symptoms, Causes and Treatment
Introduction:
An abscess is a painful collection of pus that can form anywhere in the body. It is typically caused by a bacterial infection. Abscesses can occur in various parts of the body, including the skin, mouth, lungs, brain, and abdomen.

When bacteria invade the body, the immune system responds …
Kawasaki Disease
Introduction
Kawasaki disease is a rare condition that causes inflammation in the walls of blood vessels throughout the body. It primarily affects young children under the age of five. While the exact cause of Kawasaki disease remains unknown, it is thought to be triggered by an infection.

Characterized by a …
Ataxia: What It Is, Causes, Symptoms, Treatment and Types
Introduction
Ataxia is a neurological disorder that affects coordination, balance, and speech. People with ataxia often experience difficulty with movements that require precise coordination, such as walking, writing, or speaking. Ataxia is not a disease in itself, but rather a symptom of an underlying condition.

There are many different causes …
Colitis: Symptoms, What it Is, Types and Treatment
Introduction
Colitis is a general term for inflammation of the colon. The colon, also known as the large intestine, is the final part of the digestive system. It is responsible for absorbing water and electrolytes from digested food and forming stool.

Colitis can have various causes, including infection, inflammatory bowel …
Tinea Versicolor: Symptoms, Causes and Treatments
Introduction:
Tinea versicolor is a common fungal infection that affects the skin. It is caused by a type of yeast called Malassezia globosa, which is naturally found on the skin. The condition occurs when this yeast overgrows, leading to changes in skin pigmentation. Tinea versicolor is not contagious and typically …
Addisons Disease: What It Is, Causes, Symptoms and Treatment
Introduction
Addison's disease, also known as adrenal insufficiency, is a rare endocrine disorder that occurs when the adrenal glands do not produce enough of certain hormones, primarily cortisol and aldosterone. Cortisol, often referred to as the “stress hormone,” plays a vital role in helping the body respond to stress, regulate …
Gangrene: Definition, Symptoms, Treatment, Causes
Introduction
Gangrene is a serious condition that occurs when blood flow to a certain area of the body is interrupted, leading to tissue death. It is a medical emergency that requires immediate treatment to prevent potentially life-threatening complications.
Gangrene can affect various body parts, including the toes, fingers, limbs, and …
Stroke: What It Is, Causes, Symptoms, Treatment and Types
Introduction
A stroke is a medical emergency that occurs when blood flow to a part of the brain is interrupted or reduced, depriving brain tissue of oxygen and nutrients. Within minutes, brain cells begin to die. Stroke is a leading cause of death and long-term disability worldwide.

There are two …
Scleroderma: Types, Symptoms, Diagnosis and Treatment
Introduction:
Scleroderma, also known as systemic sclerosis, is a rare autoimmune disease that affects the connective tissues. This chronic condition causes the body to produce an excess of collagen, leading to a hardening and thickening of the skin and internal organs. Scleroderma can present a wide range of symptoms and …
Menopause: What It Is, Age, Stages, Signs and Side Effects
Introduction:
Menopause is a natural biological process marking the end of a woman's menstrual cycles. It is a significant life transition that brings about various physical and emotional changes due to the decline in estrogen production. Understanding menopause, its stages, and potential symptoms can empower women to navigate this phase …
Albinism: Types, Symptoms and Causes
Introduction
Albinism is a rare genetic condition that affects the production of melanin, the pigment responsible for giving color to our skin, hair, and eyes. Individuals with albinism have little or no melanin, which results in characteristic features such as very pale skin, white or light blonde hair, and light-colored …
Rhabdomyolysis: Symptoms, Causes and Treatments
Introduction
Rhabdomyolysis is a serious medical condition that occurs when damaged skeletal muscle breaks down rapidly. When muscle cells are damaged, they release their contents, including a protein called myoglobin, into the bloodstream. While myoglobin is normally present in muscle tissue, high levels in the blood can harm the kidneys …
Heart Murmur: Causes, Symptoms, Treatment
Introduction:
A heart murmur is an extra or unusual sound heard during a heartbeat. These sounds, which can be described as whooshing or swishing, are created by turbulent blood flow in or near the heart. While some heart murmurs are harmless and don't require treatment (known as innocent murmurs), others …
HIV,AIDS: Symptoms, Treatment, and Prevention
Introduction:
HIV, or the human immunodeficiency virus, is a virus that attacks the body's immune system, specifically the CD4 cells (T cells), which help the body fight off infection. Over time, HIV can destroy so many of these cells that the body can't fight off infections and diseases. When this …
Understanding Epilepsy: Symptoms and Treatment
Introduction:
Epilepsy is a neurological disorder that affects the central nervous system, causing recurring seizures. These seizures are episodes of abnormal brain activity that can manifest in various ways, ranging from brief periods of staring to prolonged convulsions. Understanding epilepsy, including its symptoms, causes, and available treatment options, is crucial …
Mastitis: Causes, Symptoms, Treatment and Prevention
Introduction:
Mastitis is an inflammation of breast tissue that can cause pain, swelling, warmth, and redness in the affected breast. It can also cause fever, chills, and body aches. Mastitis is most common in women who are breastfeeding, but it can also occur in women who are not breastfeeding and …
Cellulite: What It Is, Causes and Treatment
What is Cellulite?
Cellulite is a common skin condition that gives the skin a dimpled, lumpy appearance. It's sometimes described as having a cottage cheese or orange peel texture. Cellulite occurs when fat deposits push through the connective tissue beneath the skin. It most commonly appears on the thighs, buttocks …
Cradle Cap: What It Is, Symptoms and Treatment
Introduction
Cradle cap, also known as infantile seborrheic dermatitis, is a common skin condition that affects infants. It is characterized by yellowish, greasy, scaly patches on the scalp. While it can look alarming, cradle cap is harmless and typically clears up on its own within a few weeks or months …
Molluscum Contagiosum: Symptoms, Causes and Treatment
Introduction
Molluscum contagiosum is a common skin infection caused by a poxvirus. It's highly contagious and characterized by small, raised, pearly or flesh-colored bumps on the skin. These bumps, called mollusca, are usually painless but can sometimes become itchy or irritated.

While molluscum contagiosum can affect anyone, it's most prevalent …
Pilonidal Cyst: Causes, Symptoms, Treatments and Removal
Introduction
A pilonidal cyst is a painful, fluid-filled lump that develops near the tailbone at the top of the buttocks crease. While pilonidal cysts can sometimes go unnoticed, an infected cyst can cause significant discomfort and may require medical attention.
The exact cause of pilonidal cysts is unclear, but several …
Sjogrens Syndrome: Causes, Symptoms, Diagnosis and Treatments
Introduction
Sjögren's syndrome is a chronic autoimmune disorder that affects the body's moisture-producing glands. It primarily targets the salivary and lacrimal glands, leading to dryness of the mouth and eyes. While the exact cause of Sjögren's syndrome remains unknown, it is believed to involve a combination of genetic predisposition and …
Misophonia: What It Is, Triggers, Symptoms and Treatment
Introduction:
Misophonia, meaning "hatred of sound", is a disorder characterized by a strong dislike or hatred of specific sounds. People with misophonia experience intense negative emotions, such as anger, anxiety, or disgust, when they hear these trigger sounds. Common triggers include chewing, slurping, tapping, and other repetitive noises. Although the …
Chigger Bites: What they Look Like, Treatment and Prevention
Introduction:
Chiggers, those tiny red mites that lurk in tall grass and weeds, are a common summertime nuisance. While their bites aren't dangerous, they can cause intense itching and discomfort. Understanding what chigger bites look like, how to treat them, and how to prevent them can help you enjoy the …
Heart Palpitations: Symptoms, Causes and Treatment
Introduction
Heart palpitations are a common experience characterized by a noticeable awareness of your heartbeat. This sensation can manifest as a fluttering, pounding, racing, or skipping beat in your chest. While often harmless, heart palpitations can sometimes signal an underlying medical condition.

For most people, heart palpitations are occasional and …
Dystonia
Understanding Dystonia
Dystonia is a neurological movement disorder characterized by involuntary muscle contractions that cause repetitive or twisting movements and abnormal postures. These movements can affect any part of the body, including the arms, legs, trunk, neck, eyelids, and face. Dystonia can range from mild and occasional to severe and …
Peripheral Neuropathy: What It Is, Symptoms and Treatment
Introduction
Peripheral neuropathy is a condition that arises from damage to the peripheral nervous system, a complex network of nerves that transmit signals between the brain and spinal cord to the rest of the body. This intricate system plays a crucial role in controlling sensation, movement, and bodily functions. When …
Hepatitis A: What It IS, Symptoms, Transmission and Treatment
Introduction
Hepatitis A is a highly contagious liver infection caused by the hepatitis A virus (HAV). It is a common illness worldwide, with varying incidence rates depending on sanitation and hygiene practices. Unlike other types of hepatitis (B and C), Hepatitis A does not cause chronic liver disease, and most …
Botulism: Types, Causes, Symptoms and Treatments
Introduction
Botulism is a rare but serious illness caused by a toxin produced by the bacterium Clostridium botulinum. This toxin, known as botulinum toxin, is one of the most potent poisons known to humankind. Botulism can affect anyone, regardless of age or health status, and can be fatal if not …
What Is Blood Pressure
Introduction
Blood pressure is the force of your blood pushing against the walls of your arteries. Each time your heart beats, it pumps blood into the arteries. Your blood pressure is highest when your heart beats, pumping the blood. This is called systolic pressure. When your heart is at rest …
Williams Syndrome, Williams Beuren Syndrome: Causes, Symptoms and Treatment
Introduction
Williams syndrome, also known as Williams-Beuren syndrome, is a rare genetic disorder that affects an estimated 1 in 7,500 to 20,000 people worldwide. This condition is present at birth and can impact various aspects of an individual's physical and cognitive development. Individuals with Williams syndrome often exhibit …
Anthrax: Bacillus anthracis, Symptoms, Types, Causes, Treatment
Introduction
Anthrax is a serious infectious disease caused by the bacterium Bacillus anthracis. This rod-shaped bacterium is found naturally in soil and commonly affects domestic and wild animals around the world. Anthrax can be found on all continents, but the most affected areas are agricultural regions of Central and South …
Gastroparesis: Symptoms, Causes, Diagnosis and Treatment
Introduction:
Gastroparesis, also known as delayed gastric emptying, is a condition that affects the stomach muscles and prevents proper digestion. In a healthy digestive system, strong muscular contractions move food from the stomach to the small intestine. However, in individuals with gastroparesis, these contractions are weakened or absent, resulting in …
Pancreatic Cancer: Symptoms, Causes and Treatment
Introduction
Pancreatic cancer is a disease in which malignant (cancerous) cells form in the tissues of the pancreas. The pancreas is a gland located in the abdomen. It produces hormones that regulate blood sugar and enzymes that help with digestion. Unfortunately, this type of cancer is difficult to detect early …
Atrial Fibrillation Afib: Causes, Symptoms and Treatment
Introduction
Atrial fibrillation (Afib) is a common type of heart rhythm disorder that affects millions of people worldwide. It occurs when the heart's upper chambers (the atria) beat irregularly and quickly, resulting in a rapid and often irregular heartbeat. Afib can lead to a variety of symptoms, including palpitations, shortness …
Thrombocytopenia: Symptoms, Stages and Treatment
Introduction:
Thrombocytopenia is a condition characterized by a lower than normal platelet count in the blood. Platelets are small, colorless blood cells that play a crucial role in blood clotting. They help stop bleeding by clumping together to form plugs at the site of an injury. When the platelet count …
Lewy Body Dementia LBD: What It Is, Symptoms and Treatment
Introduction:
Lewy body dementia (LBD) is a progressive brain disorder that affects thinking, memory, and movement. It is the second most common type of dementia after Alzheimer's disease. LBD is caused by the buildup of abnormal protein deposits, called Lewy bodies, in the brain. These deposits disrupt the brain's normal …
Syncope: Symptoms, Causes and Treatments
Introduction:
Syncope, commonly known as fainting, is a temporary loss of consciousness caused by a sudden decrease in blood flow to the brain. It's a relatively common occurrence, affecting people of all ages. While not always serious, syncope can sometimes indicate an underlying medical condition. Understanding its symptoms, causes, and …
Dyshidrotic Eczema, Dyshidrosis: Symptoms, Causes, Treatments
Introduction
Dyshidrotic eczema, also known as dyshidrosis, is a common skin condition that causes small, itchy blisters to form on the palms of your hands and soles of your feet. These blisters are usually filled with fluid and can be very uncomfortable. In some cases, the blisters may also spread …
Hydrocephalus: What It Is, Causes, Symptoms, Diagnosis and Treatment
Introduction
Hydrocephalus is a condition that occurs when there is an excessive buildup of cerebrospinal fluid (CSF) in the brain. CSF is a clear, colorless fluid that surrounds the brain and spinal cord, providing cushioning and protection. Normally, CSF flows through the brain's ventricles (hollow spaces) and is absorbed into …
Bursitis: Types, Treatment and Prevention
Introduction
Bursitis is a painful condition that affects the small, fluid-filled sacs called bursae. These sacs act as cushions between bones, tendons, and muscles near your joints, reducing friction and allowing for smooth movement. When a bursa becomes inflamed, it causes pain, stiffness, and swelling in the affected area.

Bursitis …
Fungal Infection, Mycosis: Types, Causes and Treatments
Introduction:
Fungal infections, also known as mycoses, are common ailments that can affect various parts of the body. They occur when microscopic fungi invade the body's tissues, leading to a range of symptoms depending on the location and severity of the infection. While some fungal infections are mild and easily …
Pityriasis Rosea, Christmas Tree Rash: Causes and Treatment
Introduction:
Pityriasis rosea is a common skin condition that causes a temporary rash on the body. It's characterized by its unique appearance, often resembling a Christmas tree on the back, hence the nickname "Christmas tree rash." While it can be itchy and unsightly, pityriasis rosea is harmless and usually clears …
UTI in Toddlers and Children: Causes, Symptoms and Treatment
Introduction:
Urinary tract infections (UTIs) are common infections that can affect anyone, including toddlers and children. UTIs occur when bacteria enter the urinary tract through the urethra and multiply in the bladder. While UTIs can be painful and uncomfortable, they are usually easily treatable with antibiotics.

UTIs are more common …
Emphysema: Causes, Symptoms, Diagnosis and Treatment
Introduction
Emphysema is a chronic lung condition that falls under the umbrella of chronic obstructive pulmonary disease (COPD). This progressive disease primarily affects the alveoli, which are tiny air sacs in the lungs responsible for the exchange of oxygen and carbon dioxide. Over time, emphysema causes the walls of these …
Spina Bifida: Types, Tests, Treatment and Prevention
Introduction:
Spina bifida is a birth defect that occurs when the spine doesn't form completely during pregnancy. This can cause a range of disabilities, from mild to severe. The severity of spina bifida depends on the size and location of the opening in the spine, as well as the type …
Edema: Causes, Symptoms and Treatment
Introduction
Edema is swelling caused by excess fluid trapped in your body’s tissues. It can affect any part of the body, but it’s most common in the hands, arms, feet, ankles and legs.

Edema is often a symptom of an underlying medical condition, such as heart failure, kidney …
Croup: Causes, Symptoms and Treatment
Introduction
Croup is a common respiratory condition that affects young children. It's characterized by a distinctive barking cough, often described as sounding like a seal bark. This cough arises from swelling and inflammation around the vocal cords, trachea (windpipe), and bronchi (the airways that branch into the lungs).

Croup is …
Testicular Torsion: Causes, Symptoms, Diagnosis and Treatment
Introduction
Testicular torsion is a serious medical condition that occurs when the spermatic cord, which supplies blood to the testicle, becomes twisted. This twisting cuts off the blood supply to the testicle, causing sudden and severe pain. Testicular torsion is a urological emergency that requires immediate medical attention. If left …
Skin Tags, Acrochordons: Skin Tag Removal, Skin Tag on Eyelid
Introduction
Skin tags, also known as acrochordons, are small, soft, benign growths that protrude from the skin. They are incredibly common and generally harmless. While they can occur anywhere on the body, they are most commonly found in areas where skin rubs against skin, such as the neck, armpits, eyelids …
Low Blood Pressure, Hypotension
Introduction
Low blood pressure, also known as hypotension, occurs when your blood pressure reading is significantly lower than the normal range. While blood pressure is typically viewed as a health concern when it's high, having blood pressure that's too low can also cause problems. A normal blood pressure reading is …
Marfan Syndrome: Causes, Symptoms, Diagnosis and Treatments
Introduction
Marfan syndrome is a genetic disorder that affects the body’s connective tissue. Connective tissue is found throughout the body and provides strength and flexibility to structures such as bones, ligaments, muscles, blood vessels, and heart valves.

People with Marfan syndrome have a defect in the gene that makes …
Roseola, Sixth Disease: Symptoms, Causes, Treatment and Prevention
Introduction
Roseola, also known as sixth disease or exanthem subitum, is a common viral illness that primarily affects young children, typically between six months and two years of age. It is usually caused by the human herpesvirus 6 (HHV-6), though it can also be caused by human herpesvirus 7 (HHV-7 …
Tachycardia: Symptoms, Causes and Treatment
Introduction:
Tachycardia is a condition that causes the heart to beat faster than normal while at rest. A normal resting heart rate for adults ranges from 60 to 100 beats per minute (bpm). With tachycardia, the heart rate is over 100 bpm. Many people with tachycardia experience no symptoms or …
Tetanus, Lockjaw: Symptoms and Causes
Introduction
Tetanus, also known as lockjaw, is a serious bacterial infection that affects the nervous system. It’s characterized by painful muscle contractions, particularly in the jaw and neck. Tetanus is caused by a toxin produced by the bacterium Clostridium tetani, which is commonly found in soil, dust, and manure …
Balanitis: Causes, Symptoms, Treatment and Prevention
Introduction
Balanitis is an inflammation of the head of the penis. It's a common condition that can affect males of all ages, though it's more frequent in uncircumcised males. Balanitis can be uncomfortable and sometimes painful, but it's usually not serious. In most cases, it can be effectively treated with …
Hemangioma: Types, Causes and Treatments
Introduction
A hemangioma is a benign (non-cancerous) tumor made up of blood vessels. They are the most common type of tumor in infants and children. Hemangiomas typically appear as a red, raised area of skin. While they can occur anywhere on the body, they are most often found on the …
What Is Hemophilia
What Is Hemophilia?
Hemophilia is a rare genetic bleeding disorder in which the blood doesn't clot normally. This is caused by a deficiency in clotting factors, which are proteins in the blood that help control bleeding. People with hemophilia can experience prolonged bleeding after injuries or surgeries, and they may …
Pericarditis: Causes, Symptoms and Treatment
Introduction
Pericarditis is an inflammation of the pericardium, the sac-like membrane that surrounds the heart. It can cause chest pain, shortness of breath and other symptoms. Pericarditis is usually caused by a viral infection, but it can also be caused by other factors such as bacterial infections, heart surgery, and …
Aspergers Syndrome: Management and Treatment
Introduction
Asperger's Syndrome, now widely recognized as part of the Autism Spectrum Disorder (ASD), is a neurodevelopmental condition that impacts an individual's social interactions, communication, and behavior. While there is no "cure" for Asperger's, various management and treatment strategies can significantly improve the quality of life for individuals diagnosed with …
Necrotizing Fasciitis: Causes, Symptoms and Treatment
Introduction
Necrotizing fasciitis, often referred to as "flesh-eating bacteria," is a rare but serious bacterial infection. This infection affects the fascia, which is the connective tissue surrounding muscles, nerves, fat, and blood vessels. While rare, necrotizing fasciitis spreads quickly and can be life-threatening if not treated promptly.
This comprehensive blog …
Heartburn: What It Feels Like, Causes and Treatment
Introduction
Heartburn, also known as acid indigestion, is a common condition characterized by a burning sensation in the chest, just behind the breastbone. This discomfort often rises up towards the neck and throat, leaving an unpleasant, bitter taste in the mouth. While occasional heartburn is usually nothing to worry about …
Turner Syndrome: Causes, Symptoms, Diagnosis and Treatment
Introduction
Turner syndrome is a rare genetic disorder that affects females. It occurs when one of the two X chromosomes is missing or partially missing. This chromosomal abnormality can lead to a variety of physical characteristics and health problems.

The effects of Turner syndrome vary widely among individuals, and some …
Hyperlipidemia, High Cholesterol: Levels, Causes, Symptoms and Diagnosis
Introduction
Hyperlipidemia, commonly known as high cholesterol, is a condition that affects millions worldwide. It is characterized by elevated levels of lipids, primarily cholesterol and triglycerides, in the bloodstream. While cholesterol is essential for various bodily functions, excessive levels can lead to serious health problems, particularly cardiovascular disease.

This comprehensive …
Serotonin Syndrome: What It Is, Causes, Symptoms and Treatment
Introduction
Serotonin syndrome is a potentially life-threatening condition that occurs when there is too much serotonin in the body. Serotonin is a neurotransmitter, a chemical that helps nerve cells communicate with each other. It plays a role in many important functions, including mood, sleep, appetite, and digestion.

Serotonin syndrome can …
Vitamin D Deficiency: Causes, Symptoms and Treatment
Introduction
Vitamin D is an essential nutrient that plays a vital role in many bodily functions, including bone health, immune function, and cell growth. While our bodies can produce vitamin D when our skin is exposed to sunlight, many individuals experience vitamin D deficiency due to various factors.

Vitamin D …
Carpal Tunnel Syndrome: Symptoms, Causes and Treatment
Introduction
Carpal tunnel syndrome is a common condition that causes pain, numbness, and tingling in the hand and arm. It occurs when the median nerve, which runs from your forearm into your hand, becomes compressed at the wrist.

The carpal tunnel is a narrow passageway surrounded by bones and ligaments …
Ingrown Hair: What It Looks Like, Causes, Treatment and Prevention
Introduction
An ingrown hair occurs when a hair curls back or grows sideways into the skin instead of growing outward. This can cause inflammation, pain, and sometimes infection. Ingrown hairs are a common condition, especially for people with curly or coarse hair. They can occur anywhere on the body where …
Vasculitis: Symptoms, Diagnosis and Treatment
Introduction
Vasculitis is a general term for a group of diseases that cause inflammation of the blood vessels. The inflammation can cause the walls of the blood vessels to thicken, which reduces the width of the passageway through the vessel. This can reduce blood flow, leading to organ and tissue …
Jock Itch: What It Is, Symptoms and Treatment
Introduction
Jock itch (tinea cruris) is a common fungal infection that affects the skin of the groin, inner thighs, and buttocks. It's caused by a type of fungus called dermatophytes, which thrive in warm, moist environments. While jock itch can be itchy and uncomfortable, it's usually a mild infection that …
Hammertoes: Causes, Relief and Treatment
Introduction
Hammertoe is a foot deformity that causes an abnormal bend in the middle joint of a toe, making it resemble a hammer. This condition typically affects the second, third, or fourth toe and can cause pain, discomfort, and difficulty walking. While hammertoes can develop at any age, they are …
Decidual Cast: Shedding, Causes, Pain and Treatment
Introduction:
The term "decidual cast" might sound intimidating, but it refers to a rare gynecological phenomenon that involves the shedding of the entire lining of the uterus (the endometrium) in one piece, resembling a cast of the uterine cavity. While it can be alarming, a decidual cast is not typically …
Hodgkin Lymphoma: Symptoms, Diagnosis, Causes and Treatment
Introduction
Hodgkin lymphoma is a type of cancer that affects the lymphatic system, a crucial part of the body's immune system. It arises when lymphocytes, a type of white blood cell, grow abnormally and spread beyond the lymph nodes. This can lead to a range of symptoms and potentially life-threatening …
Kidney Infection, Pyelonephritis: Symptoms and Treatment
Introduction
A kidney infection, also known as pyelonephritis, is a serious condition that occurs when bacteria infect the kidneys. It typically develops as a complication of a urinary tract infection (UTI) that spreads from the bladder to one or both kidneys. Kidney infections require prompt medical attention to prevent potentially …
Pleurisy: Causes, Symptoms, Diagnosis, Treatment and Prevention
Introduction
Pleurisy, also known as pleuritis, is a condition that affects the thin layers of tissue lining the lungs and chest cavity, known as the pleura. These membranes act as lubricants, allowing the lungs to move smoothly within the chest during breathing. Pleurisy occurs when these layers become inflamed, causing …
Salmonella: Outbreaks, Causes, Symptoms and Treatment
Introduction
Salmonella is a type of bacteria that can cause food poisoning. It’s one of the most common causes of foodborne illness in the United States. According to the Centers for Disease Control and Prevention (CDC), salmonella bacteria cause about 1.35 million infections, 26,500 hospitalizations, and 420 …
Hypoxia: Causes, Symptoms, Tests, Diagnosis and Treatment
Introduction
Hypoxia is a condition that occurs when the body's tissues do not receive enough oxygen. This can happen for a variety of reasons, such as a problem with the lungs or circulatory system. Hypoxia can be a serious condition, and it is important to seek medical attention if you …
Clinical Depression, Major Depressive Disorder: Symptoms
Introduction
Clinical depression, also known as major depressive disorder (MDD), is a common and serious medical illness that negatively affects how you feel, the way you think and how you act. It can lead to a variety of emotional and physical problems and can decrease a person’s ability to …
Milia, Milk Spots: Causes and Treatment
Introduction:
Milia are small, white bumps that commonly appear on the skin, often around the eyes, nose, and cheeks. These harmless cysts are filled with keratin, a protein found in skin. While milia can affect people of all ages, they are particularly common in newborns.

Often mistaken for whiteheads, milia …
Lymphedema: Symptoms, Causes and Treatment
Introduction
Lymphedema is a chronic condition that causes swelling, most often in the arms or legs. It occurs when the lymphatic system, a crucial part of the body’s immune and circulatory systems, is compromised. This system comprises a network of lymph nodes and vessels that transport lymph, a fluid …
Cardiac Arrest: Symptoms, Causes and Treatment
Introduction
Cardiac arrest is a serious medical emergency that occurs when the heart suddenly stops beating. This prevents blood from flowing to the brain, lungs, and other vital organs. Cardiac arrest is often fatal if not treated immediately.

Cardiac arrest is not the same as a heart attack. A heart …
Diverticulosis: What It Is, Symptoms, Causes and Treatment
Introduction
Diverticulosis is a condition that affects the digestive system, particularly the large intestine (colon). It's characterized by the formation of small pouches, called diverticula, protruding outward from the colon wall. These pouches are usually harmless and often don't cause noticeable symptoms. However, they can sometimes become inflamed or infected …
Cardiomyopathy: Symptoms and Treatment
Introduction
Cardiomyopathy is a serious heart condition that affects the heart muscle's ability to pump blood effectively. This can lead to a variety of symptoms, including shortness of breath, fatigue, and swelling in the legs and feet. If left untreated, cardiomyopathy can lead to heart failure, stroke, or sudden cardiac …
Sarcoidosis: Causes, Symptoms, Diagnosis and Treatment
Introduction
Sarcoidosis is an inflammatory disease that affects multiple organs in the body, most commonly the lungs and lymph nodes. It occurs when clusters of inflammatory cells, known as granulomas, form in these organs. While the exact cause of sarcoidosis is unknown, it is believed to be triggered by a …
Scalp Psoriasis: Symptoms, Plaque, Causes and Treatment
Introduction:
Scalp psoriasis is a common skin condition that causes red, itchy, and scaly patches to develop on the scalp. It is a chronic, autoimmune disease, meaning that it is caused by the body’s immune system attacking healthy skin cells. Though it can occur on any part of the …
Myasthenia Gravis: Treatment and Symptoms
Introduction
Myasthenia gravis (MG) is a chronic autoimmune disease that affects the neuromuscular junction, the point where nerves connect with muscles. This interference disrupts the transmission of nerve impulses to muscles, leading to muscle weakness and fatigue. The hallmark of MG is fluctuating muscle weakness that worsens with activity and …
Epilepsy: What It Is, Causes, Symptoms, Diagnosis and Treatment
Introduction
Epilepsy is a chronic neurological disorder that affects millions of people worldwide. It is characterized by recurrent seizures, which are brief episodes of abnormal brain activity that can cause a variety of physical and cognitive symptoms. Epilepsy can have a significant impact on a person's quality of life, but …
Skin Rash: Types, Symptoms, Causes, Diagnosis and Treatments
Introduction
A skin rash is a noticeable change in the color, texture, or appearance of your skin. It can be localized to one area or affect your entire body. Rashes can vary greatly in appearance and severity, ranging from mild and temporary to severe and long-lasting.
Most skin rashes are …
Amyloidosis: What It Is, Symptoms, Types and Treatment
Introduction
Amyloidosis is a rare disease that occurs when an abnormal protein, called amyloid, builds up in your organs and tissues. Amyloid deposits can affect different organs in different people, and there is no one-size-fits-all description of what it feels like to have amyloidosis.

The buildup of amyloid can make …
Sprained Ankle: Symptoms, Types, Treatment and Recovery
Introduction
A sprained ankle is a common injury that occurs when the ligaments that support the ankle joint are stretched or torn. This typically happens when the ankle is twisted or rolled, such as during sports activities or falls. The severity of a sprained ankle can vary depending on the …
Lichen Sclerosus: Causes, Symptoms, Diagnosis and Treatment
Introduction
Lichen sclerosus is a long-term skin condition that mainly affects the genital and anal areas. It can cause itching, pain, and white patches on the skin. While it can affect people of any age, it is more common in women who have gone through menopause. Although the exact cause …
Rectal Prolapse: Symptoms, Causes and Treatment
Introduction
Rectal prolapse is a condition that occurs when the rectum, the last part of the large intestine, protrudes out of the anus. It can affect people of all ages, but it is more common in older adults. Rectal prolapse can be a distressing and uncomfortable condition, but it is …
Measles: Causes, Symptoms, Diagnosis, Treatment and Prevention
Introduction:
Measles is a highly contagious respiratory infection caused by a virus. It spreads easily through the air when an infected person coughs or sneezes. Before the measles vaccine was introduced in 1963, it was a common childhood illness. Today, thanks to widespread vaccination, measles is less common. However, outbreaks …
Metastasis, Metastatic Cancer: Definition, Biology and Types
Introduction
Metastasis is the spread of cancer cells from the primary tumor, where it originated, to other parts of the body. It is a complex process that involves several steps, including the detachment of cancer cells from the primary tumor, invasion of surrounding tissues, entry into the bloodstream or lymphatic …
Seizure: What It Is, Causes, Symptoms and Types
Introduction
A seizure is a sudden, uncontrolled electrical disturbance in the brain. It can cause a wide range of symptoms, from mild twitching to violent convulsions. Seizures can happen to anyone, at any age.

There are many different types of seizures, and they can be caused by a variety of …
Atherosclerosis: Symptoms and Treatment
Introduction
Atherosclerosis is a chronic disease that affects the arteries. It occurs when fat, cholesterol, and other substances build up in the arteries, forming plaque. This plaque can harden and narrow the arteries, reducing blood flow to vital organs. Atherosclerosis is a serious condition that can lead to heart attack …
Swimmer’s Ear: Symptoms and Treatments
Introduction
Swimmer’s ear, also known as otitis externa, is an infection of the outer ear canal, the tube that runs from your eardrum to the outside of your head. It’s often caused by water that remains in your ear after swimming, creating a moist environment that aids bacterial …
Macular Degeneration: Symptoms, Diagnosis and Treatment
Introduction
Macular degeneration, also known as age-related macular degeneration (AMD), is a common eye condition and a leading cause of vision loss among people aged 50 and older. It affects the macula, a small area near the center of the retina responsible for sharp, central vision needed for activities like …
Plantar Warts: Symptoms, Causes, Treatment and Removal
Introduction
Plantar warts are small, noncancerous growths that appear on the soles of the feet. They are caused by an infection with the human papillomavirus (HPV), which enters the body through tiny cuts or breaks in the skin. Plantar warts are contagious and can spread through direct contact or by …
Cirrhosis of the Liver: What is It, Symptoms, Causes and Stages
Introduction:
Cirrhosis of the liver is a late-stage liver disease in which healthy liver tissue is replaced by scar tissue, affecting the liver's ability to function. It is a serious condition that can lead to liver failure and death. Cirrhosis often develops slowly over many years, and in its early …
Dysautonomia: Symptoms, Causes, Types, and How to Live With
Introduction
Dysautonomia is a blanket term for a group of conditions that affect the autonomic nervous system. This system controls automatic functions in the body like heart rate, blood pressure, digestion, and temperature regulation. When it's not working as it should, it can cause a myriad of symptoms that range …
Listeriosis: Causes, Symptoms, Treatment and Prevention
Introduction:
Listeriosis is a serious infection caused by the bacterium Listeria monocytogenes. It primarily affects pregnant women, newborns, older adults, and individuals with weakened immune systems. While listeriosis is relatively rare, it can be life-threatening, especially for those in high-risk groups. Understanding the causes, symptoms, treatment, and prevention of listeriosis …
Eosinophilia: Definition, Symptoms, Causes and Treatment
Introduction
Eosinophilia is a condition characterized by a higher than normal level of eosinophils in the blood. Eosinophils are a type of white blood cell that plays a crucial role in the body's immune response, particularly in fighting parasitic infections and allergic reactions. While a certain level of eosinophils is …
Type 1 Diabetes: Causes, Symptoms, Complications and Treatment
Introduction
Type 1 diabetes, previously known as juvenile diabetes or insulin-dependent diabetes, is a chronic condition in which the pancreas produces little or no insulin. Insulin is a hormone that allows glucose (sugar) from the food we eat to enter our body’s cells to be used for energy. Without …
Seborrheic Keratosis: What Is It, Causes, Risks and Treatment
Introduction
Seborrheic keratosis is a common non-cancerous skin growth. While harmless, their appearance can be bothersome for some. Seborrheic keratoses (SKs) usually appear as brown, black or light tan growths on the face, chest, shoulders or back. They have a characteristic waxy, "stuck-on" appearance.

This article will explore the causes …
Scarlet Fever: Symptoms, Causes and Treatment
Introduction
Scarlet fever is a bacterial infection that mainly affects children. It's characterized by a distinctive bright red rash that feels like sandpaper. While once a serious childhood illness, scarlet fever is now less common and easily treatable with antibiotics. However, it's important to be aware of its symptoms and …
Ganglion Cysts: Causes, Symptoms, Diagnosis and Treatment
Introduction
Ganglion cysts are noncancerous, fluid-filled lumps that typically develop along the tendons or joints of your wrists or hands. They can also occur in your ankles and feet. These cysts can vary in size, sometimes growing larger with increased hand activity, and may even disappear on their own.

While …
Shin Splints: Causes, Symptoms, Treatment and Prevention
Introduction:
Shin splints, medically known as medial tibial stress syndrome (MTSS), are a common complaint among runners and athletes. This condition causes pain along the inner edge of the shinbone (tibia), typically brought on by overuse or repetitive stress on the lower legs. While the pain can be debilitating, understanding …
Narcissistic Personality Disorder: Traits, Tests, Treatment
Introduction
Narcissistic Personality Disorder (NPD) is a complex mental health condition characterized by an inflated sense of self-importance, a deep need for admiration, and a lack of empathy for others. Individuals with NPD often struggle to maintain healthy relationships and may experience significant distress in their personal and professional lives …
Achilles Tendinitis: Achilles Tendon Pain, Treatment
Introduction
Achilles tendinitis is a common injury that causes pain and inflammation in the Achilles tendon, a strong, fibrous cord that connects the calf muscles to the heel bone. The Achilles tendon is the largest tendon in the body, and it plays an important role in walking, running, and jumping …
Osteopenia, Low Bone Density: What Is It, Prevention, Symptoms, Causes and Treatment
Introduction
Osteopenia, often referred to as low bone density, is a condition where bone mineral density is lower than normal, but not low enough to be classified as osteoporosis. It signifies a weakening of the bones, making them more susceptible to fractures. While osteopenia is not as severe as osteoporosis …
Peyronie’s Disease: Causes, Symptoms, Diagnosis and Treatment
Introduction
Peyronie's disease is a condition that affects the penis, causing it to curve abnormally. This curvature can make sexual intercourse painful or even impossible. The condition develops when scar tissue, also known as plaque, forms inside the penis. While the exact cause of Peyronie's disease is unknown, it is …
Hemlock Poisoning: Symptoms, Treatment and Prevention
Introduction:
Poison hemlock (Conium maculatum) is a highly poisonous plant found throughout the United States. It is often found in ditches, fields, and other disturbed areas. All parts of the plant are poisonous, but the seeds and roots are the most toxic. Hemlock poisoning can occur if the plant is …
Headache: What It Is, Types, Causes, Symptoms and Treatment
Introduction
A headache is a pain in the head, ranging from mild and temporary to severe and debilitating. Headaches are one of the most common health complaints, with most people experiencing headaches from time to time.
Headaches can be caused by a variety of factors, including stress, tension, eye strain …
Myocarditis: Symptoms and Causes
Introduction
Myocarditis is an inflammation of the heart muscle, known as the myocardium. This condition can weaken the heart, affecting its ability to pump blood effectively and potentially leading to heart rhythm abnormalities.
Myocarditis can result from a variety of factors, including viral infections, bacterial infections, autoimmune diseases, and reactions …
Warts: HPV, Causes, Types, Treatments, Removal, Prevention
Introduction
Warts are small, noncancerous growths that appear on the skin. They are caused by the human papillomavirus (HPV), which infects the top layer of skin. Warts are contagious and can spread through direct contact with an infected person or by touching surfaces that have been contaminated with the virus …
Atelectasis: Causes, Symptoms, Diagnosis and Treatment
Introduction:
Atelectasis is a respiratory condition characterized by the collapse of part or all of a lung. This occurs when the tiny air sacs (alveoli) within the lung deflate or fill with fluid, preventing the exchange of oxygen and carbon dioxide. Atelectasis can range in severity from mild and asymptomatic …
Hangover: Symptoms, Remedies, Cure, Prevention
Introduction
A hangover is a group of unpleasant signs and symptoms that can develop after drinking too much alcohol. Hangovers are generally short-lived, typically lasting less than 24 hours. The severity of a hangover can vary depending on how much alcohol you drank, how much you ate before drinking, and …
Gestational Diabetes: Causes, Diagnosis & Treatments
Introduction:
Gestational diabetes is a type of diabetes that develops during pregnancy. It affects how your body uses sugar (glucose) and can cause high blood sugar levels that can affect your pregnancy and your baby's health.
While it can seem alarming, gestational diabetes is manageable. With careful monitoring and treatment …
Vaginal Yeast Infection: Causes, Symptoms & Treatment
Introduction
A vaginal yeast infection, also known as vaginal candidiasis, is a common fungal infection that causes irritation, discharge, and intense itchiness in the vagina and vulva — the tissues at the vaginal opening. While bothersome, yeast infections are rarely serious and can be effectively treated with antifungal medications.

Yeast infections …
Tennis Elbow: What it is, Causes, Symptoms & Treatment
Introduction:
Tennis elbow, also known as lateral epicondylitis, is a painful condition that affects the tendons on the outside of the elbow. Despite its name, you don't have to be a tennis player to develop this condition. In fact, any activity that involves repetitive arm movements can lead to tennis …
Polio: Virus, Causes, Symptoms, Transmission & Treatment
Introduction
Polio is a highly contagious viral disease that can cause paralysis and even death. It is caused by the poliovirus, which invades the nervous system and can cause irreversible damage in a matter of hours. Although there is no cure for polio, it can be prevented through vaccination.
Polio …
Spinal Stenosis: What is It, Symptoms, Causes, Treatment & Surgery
Introduction
Spinal stenosis is a condition that occurs when the spaces within your spine narrow, putting pressure on your spinal cord and the nerves that travel through your spine. This narrowing can happen anywhere along your spine, but it’s most common in the lower back (lumbar spine) and neck …
Trigeminal Neuralgia: Symptoms, Causes, Treatment & Surgery
Introduction
Trigeminal neuralgia (TN), also known as tic douloureux, is a chronic pain condition that affects the trigeminal nerve, which carries sensation from your face to your brain. It’s characterized by episodes of sudden, severe, and shooting or stabbing pain in parts of the face, usually on one side …
Mouth Ulcer: What Is It, Symptoms, Causes & Treatment
Introduction:
A mouth ulcer, also known as a canker sore, is a small, shallow lesion that develops on the soft tissues in your mouth or at the base of your gums. Unlike cold sores, mouth ulcers don't occur on the surface of your lips and aren't contagious. They can be …
Smegma: What It Is, Prevention & How To Get Rid Of It
Introduction:
Smegma is a natural secretion that can accumulate under the foreskin of the penis or around the folds of the labia. It's usually harmless but can become a problem if it builds up and isn't cleaned regularly.
This whitish substance is comprised of dead skin cells, skin oils, and …
Dysuria (Painful Urination): Treatment, Causes & Symptoms
Introduction
Dysuria, or painful urination, is a common condition that can affect people of all ages. It is characterized by a burning or stinging sensation during urination, and it can be accompanied by other symptoms such as frequency, urgency, and hesitancy. Dysuria can be caused by a variety of factors …
Ankylosing Spondylitis AS: Symptoms, Causes and Treatment
Introduction
Ankylosing spondylitis (AS) is a type of arthritis that mainly affects the spine. It causes inflammation of the vertebrae that can lead to severe, chronic pain and discomfort. Over time, the inflammation can lead to new bone formation on the spine, causing sections of the spine to fuse in …
Arrhythmia: Symptoms & Treatment
Introduction
An arrhythmia is a problem with the rate or rhythm of your heartbeat. During an arrhythmia, the heart can beat too fast, too slow, or with an irregular rhythm. Arrhythmias are common, and many are harmless. However, some arrhythmias can be serious or even life-threatening.

Arrhythmias can occur for …
Gingivitis: Symptoms and How To Treat It
Introduction:
Gingivitis is a common and mild form of gum disease (periodontal disease) that causes irritation, redness, and swelling of your gingiva, the part of your gum surrounding the base of your teeth. It's important to take gingivitis seriously and treat it promptly. Gingivitis can lead to much more serious …
Fordyce Spots: Symptoms, Causes, Treatment & On Lips
Introduction
Fordyce spots are small, painless, pale bumps that can appear on the skin of the lips, genitals, and other areas. They are harmless and not contagious. Fordyce spots are sebaceous glands, which are responsible for producing sebum, an oily substance that lubricates the skin and hair. In most cases …
Allergies: Symptoms, Reaction, Treatment & Management
Introduction
Allergies are an overreaction of the immune system to typically harmless substances in the environment. These substances, known as allergens, can range from pollen and pet dander to certain foods and medications. When someone with an allergy comes into contact with an allergen, their body releases histamine and other …
Chalazion: Symptoms, Causes, Treatments
Introduction:
A chalazion is a small, usually painless bump or swelling that develops on your eyelid. It occurs when an oil gland in the eyelid becomes blocked. Chalazia are common and often don't require treatment if they are small and not bothering you. However, larger chalazia can cause discomfort, blurry …
Piriformis Syndrome: Symptoms, Causes and Treatment
Introduction
Piriformis syndrome is a condition that occurs when the piriformis muscle, a small muscle located deep in the buttock, compresses or irritates the sciatic nerve. The sciatic nerve is a large nerve that runs from the lower back down the back of each leg. Piriformis syndrome can cause pain …
Basal Cell Carcinoma: Causes, Symptoms & Treatment
Introduction:
Basal cell carcinoma (BCC) is the most common type of skin cancer. It typically appears as a pearly or waxy bump, often on sun-exposed areas like the face, ears, and neck. While BCC rarely spreads to other parts of the body, early detection and treatment are essential to prevent …
ACL Tear: Symptoms, Recovery & Treatment
Introduction
The anterior cruciate ligament (ACL) is one of the major ligaments in your knee. It connects your thighbone (femur) to your shinbone (tibia) and helps stabilize the knee joint. An ACL tear is a common knee injury, often occurring during sports and other activities that involve sudden stops or …
Squamous Cell Carcinoma: Symptoms, Causes & Treatment
Introduction:
Squamous cell carcinoma (SCC) is a common type of skin cancer that develops in the squamous cells, which make up the middle and outer layers of the skin. It often appears as a firm, red nodule or a scaly, crusted lesion. While SCC can occur anywhere on the body …
Hyponatremia: Causes, Symptoms, Diagnosis & Treatment
Introduction:
Hyponatremia is a condition that occurs when the concentration of sodium in your blood is abnormally low. Sodium is an essential electrolyte that helps regulate the amount of water in and around your cells. When the sodium levels in your blood become diluted, it creates an imbalance that can …
Diastasis Recti (Abdominal Separation): Symptoms & Treatment
Introduction
Diastasis recti, a condition often referred to as abdominal separation, occurs when the rectus abdominis muscles, commonly known as the "six-pack" muscles, separate at the linea alba, the connective tissue that runs down the middle of the abdomen. This separation can create a bulge or gap in the midline …
Epididymitis: Causes, Symptoms, Diagnosis & Treatment
Introduction
Epididymitis is an inflammation of the epididymis, a coiled tube located at the back of the testicle that stores and carries sperm. This condition is most common in men between the ages of 14 and 35, but it can affect males of any age.

Epididymitis can be caused by …
Perioral Dermatitis: Treatment, Symptoms & Causes
Introduction
Perioral dermatitis is a common skin condition that causes redness and inflammation around the mouth. It can be itchy and uncomfortable, and often looks like acne. While the exact cause of perioral dermatitis is unknown, there are several factors that are thought to contribute to its development. These include …
Prediabetes: What Is It, Who's at Risk, Symptoms, Can It Be Reversed
Introduction
Prediabetes is a serious health condition where blood sugar levels are higher than normal, but not high enough yet to be diagnosed as type 2 diabetes. Without lifestyle changes, adults and children with prediabetes are at high risk of progressing to type 2 diabetes. Progression away from prediabetes to …
Pinworms: Symptoms, Causes, Treatments
Introduction
Pinworms, also known as threadworms, are small, white, parasitic worms that can live in the human intestines. They are particularly common in children, but anyone can get them. Pinworms are highly contagious and spread easily through contact with contaminated surfaces or objects.

While pinworms are not usually harmful, they …
Anxiety Disorders: Types, Causes, Symptoms & Treatments
Introduction:
Anxiety is a normal human emotion that everyone experiences from time to time. It's that feeling of worry, nervousness, or unease that we get when faced with a challenging situation, like a big test, an important job interview, or a first date. However, when anxiety becomes persistent and overwhelming …
Prostate Cancer: Symptoms, Causes & Treatment
Introduction
Prostate cancer is one of the most common types of cancer in men, affecting the prostate gland, a small walnut-sized gland responsible for producing seminal fluid. While it can be a serious disease, many men diagnosed with prostate cancer live long and healthy lives, especially with early detection and …
Miscarriage: Causes, Symptoms, Risks, Treatment & Prevention
Introduction
Miscarriage, also known as spontaneous abortion, is the unexpected loss of a pregnancy before the 20th week. It's a heartbreaking experience that affects many couples, with an estimated 10-20% of known pregnancies ending in miscarriage. While the experience can be emotionally devastating, it's important to remember that miscarriage is …
What Is Autism Spectrum Disorder (ASD)?
What Is Autism Spectrum Disorder (ASD)?
Autism spectrum disorder (ASD) is a complex developmental condition that affects how a person behaves, interacts with others, communicates, and learns. It encompasses a wide range of symptoms and severities, which is why it is referred to as a "spectrum" disorder. Individuals with ASD …
Hypoglycemia (Low Blood Sugar): Symptoms & Treatment
Introduction
Hypoglycemia, or low blood sugar, is a condition that occurs when your blood glucose level falls too low. Glucose is the main source of energy for your body's cells, and when your blood sugar drops, your body can't function properly.

Hypoglycemia is most commonly associated with diabetes, but it …
Lipoma: What Is It, Causes, Symptoms, Types, Treatment
Introduction
A lipoma is a slow-growing, benign (non-cancerous) tumor made up of fat cells. Lipomas are typically found just below the skin, but they can sometimes occur deeper in the body, such as in muscles or internal organs. While they are technically tumors, they are not harmful and do not …
Mosquito Bites: What They Look Like, Why They Itch & Treatment
Introduction
Ah, summer. The time for barbeques, swimming, and… mosquito bites. These pesky insects are infamous for their itchy bites that can drive anyone crazy. But why do mosquito bites itch, and what can you do to relieve the discomfort?

When a mosquito bites you, it doesn't just suck your …
Huntington’s Disease: Genetics, Juvenile Cases & Chorea
Introduction
Huntington’s disease (HD) is a rare, inherited brain disorder that causes progressive nerve cell degeneration. This breakdown leads to a decline in mental abilities and physical control, and unfortunately, is fatal.

Huntington’s disease affects males and females equally across all races and ethnic groups. Symptoms typically begin …
Swollen Lymph Nodes (Lymphadenopathy/Adenopathy): Symptoms & Causes
Introduction
Swollen lymph nodes, also known as lymphadenopathy or adenopathy, are a common symptom of various underlying conditions. Lymph nodes are small, bean-shaped glands that are part of the lymphatic system, which plays a crucial role in the body's immune response. When the body is fighting off an infection, illness …
Rosacea: Symptoms, Causes, Triggers & Treatment
Introduction
Rosacea is a common skin condition that causes redness and visible blood vessels in your face. It may also produce small, red, pus-filled bumps. It is often mistaken for acne, eczema, or an allergic reaction. Rosacea can affect all skin types and tones, but it most commonly affects middle-aged …
Psoriatic Arthritis: Symptoms, Treatment & Living With
Introduction
Psoriatic arthritis is a chronic inflammatory disease that affects the joints and skin. It is characterized by pain, stiffness, and swelling in the joints, as well as skin lesions called psoriasis. Psoriatic arthritis can affect any joint in the body, but it most commonly affects the fingers, toes, wrists …
Narcolepsy: What It Is, Causes, Symptoms & Treatment
Introduction
Narcolepsy is a chronic neurological disorder that affects the brain's ability to regulate sleep-wake cycles. People with narcolepsy experience excessive daytime sleepiness and often fall asleep spontaneously, regardless of the situation. While the exact cause of narcolepsy is unknown, it is believed to be linked to a combination of …
Low Back Pain: Causes, Diagnosis & Treatments
Introduction
Lower back pain is one of the most common reasons people seek medical help or miss work. It can have causes that aren't due to underlying disease. It can be caused by a variety of factors, including injury, overuse, and underlying medical conditions. Back pain can range in intensity …
Hepatitis B: Symptoms, Causes & Treatment
Introduction:
Hepatitis B is a viral infection that attacks the liver and can cause both acute and chronic disease. The virus is spread through contact with the blood or other bodily fluids of an infected person. Hepatitis B is a serious condition that can lead to long-term health problems, including …
Gallstones (Cholelithiasis): Symptoms, Causes & Treatment
Introduction:
Gallstones are hardened deposits of digestive fluid that can form in your gallbladder, a small, pear-shaped organ located just below your liver on the right side of your abdomen. The gallbladder stores bile, a fluid produced by your liver to help digest fats.
Gallstones are a common ailment, affecting …
Stomach (Peptic) Ulcer: Signs, Symptoms, Causes & Treatment
Introduction:
A stomach ulcer, also known as a peptic ulcer, is a painful sore that develops on the lining of the stomach. Stomach ulcers are a relatively common condition, affecting millions of people each year. They can cause a range of symptoms, from mild indigestion to severe abdominal pain. While …
Sleep Paralysis: What Is It, Causes, Symptoms and Prevention
Introduction
Sleep paralysis is a condition in which you are aware of your surroundings, but you are unable to move or speak. It can occur when you are falling asleep or waking up. It is often accompanied by hallucinations, which can be terrifying.

Sleep paralysis is not harmful, but it …
Ingrown Toenails: Signs, Causes, Diagnosis, Treatments, Prevention
Introduction
An ingrown toenail, also known as onychocryptosis, is a common condition that occurs when the corner or side of a toenail grows into the surrounding skin. This can cause pain, redness, swelling, and even infection. Ingrown toenails most often affect the big toe, but other toes can also be …
Leukemia: Symptoms, Signs, Causes, Types & Treatment
Introduction:
Leukemia is a type of cancer that affects the blood and bone marrow, the spongy tissue inside bones where blood cells are made. It is a complex disease with various types, each with its own set of characteristics, causes, and treatments. This blog post provides a comprehensive overview of …
Gestational Hypertension: Causes, Symptoms & Treatment
Introduction
Gestational hypertension, also known as pregnancy-induced hypertension, is a condition that affects pregnant women, typically after 20 weeks of gestation. It is characterized by high blood pressure and can sometimes be accompanied by protein in the urine (proteinuria), a condition known as preeclampsia.

Gestational hypertension can pose risks to …
Hyperthyroidism: Symptoms, Causes, Treatment & Medication
Introduction:
Hyperthyroidism is a condition in which the thyroid gland produces too much thyroid hormone. The thyroid is a small, butterfly-shaped gland located in the front of the neck. It produces hormones that regulate metabolism, which is the process by which the body uses energy.

When the thyroid gland produces …
High Blood Pressure: Symptoms & Causes
Introduction
High blood pressure, also known as hypertension, is a common condition that affects millions of people worldwide. It occurs when the force of blood against your artery walls is consistently too high, putting extra strain on your heart and blood vessels.

While high blood pressure often doesn't have noticeable …
GERD (Chronic Acid Reflux): Symptoms, Treatment, & Causes
Introduction
Gastroesophageal reflux disease (GERD) is a chronic condition that occurs when stomach acid flows back up into the esophagus, the tube connecting your mouth and stomach. This backflow of acid, also known as acid reflux or heartburn, can irritate the lining of the esophagus, leading to a range of …
Osteoporosis: Symptoms, Causes, Tests & Treatment
Introduction
Osteoporosis is a condition that weakens bones, making them fragile and more likely to break (fracture). It develops slowly over time and often has no symptoms until a bone breaks. Fractures from osteoporosis most commonly occur in the hip, spine, and wrist.

While osteoporosis can affect anyone, it's most …
Tinnitus: Causes, Cures, Treatment and Definition
Causes of Tinnitus
Introduction
Tinnitus is a common condition that causes people to hear ringing, buzzing, hissing, roaring, whistling, or other sounds in their ears or head. These sounds are not external and cannot be heard by other people. Tinnitus can be intermittent or constant, and it can vary in …
Stockholm Syndrome: What It Is, Symptoms & How to Treat
What is Stockholm Syndrome?
Introduction:
Stockholm Syndrome is a psychological condition in which hostages develop positive feelings towards their captors. This paradox, where victims begin to sympathize and even defend their abusers, is a complex survival mechanism often triggered in situations involving captivity and abuse. This article will delve into …
Ovarian Cysts: Causes, Symptoms, Diagnosis & Treatment
What Causes Ovarian Cysts?
Introduction
Ovarian cysts are fluid-filled sacs that develop on one or both of the ovaries. They are common in women of reproductive age and often don't cause any symptoms. In fact, many women have ovarian cysts at some point in their lives without even realizing it …
Laryngitis: Diagnosis, Symptoms, Causes, Treatments & Recovery
Symptoms of Laryngitis
Introduction:
Laryngitis is an inflammation of the larynx, commonly known as the voice box. This inflammation causes vocal cords to swell, leading to hoarseness or even complete voice loss. It's usually temporary, lasting a week or two, and is often caused by a viral infection like a …
Inner Ear Infection: Symptoms, Signs & Causes
Inner Ear Infection Symptoms
Inner ear infections can manifest through various symptoms, often causing significant discomfort and disruption. The most common indicators of an inner ear infection include:
-
Dizziness and Vertigo: A spinning sensation or feeling off-balance is a hallmark of inner ear infections.
-
Nausea and Vomiting: Often accompanying dizziness …
Folliculitis: Appearance, Causes, Symptoms & Treatment
Status: published
Folliculitis: Appearance, Causes, Symptoms & Treatment
Introduction
Folliculitis is a common skin condition characterized by inflammation of hair follicles. It can affect people of all ages and occurs when hair follicles become infected or irritated. Let’s explore the appearance, causes, symptoms, and treatment options for folliculitis.

Appearance
- Red …
Fetal Alcohol Syndrome (FAS): Symptoms, Causes & Treatment
Status: published
Fetal Alcohol Syndrome (FAS): Symptoms, Causes & Treatment
Fetal Alcohol Syndrome (FAS) is a serious condition that affects babies exposed to alcohol during pregnancy. In this article, we’ll explore the symptoms, causes, and treatment options for FAS.
-%20Symptoms,%20Causes%20&%20Treatment.jpeg)
Introduction
FAS occurs when a pregnant woman consumes alcohol, which can …
Cystic Fibrosis (CF): Causes, Symptoms, Diagnosis & Treatment
Cystic Fibrosis (CF): Causes, Symptoms, Diagnosis & Treatment
Cystic fibrosis (CF) is a genetic disorder that primarily affects the respiratory and digestive systems. Let’s delve into the key aspects of CF, from its causes to available treatments.
-%20Causes,%20Symptoms,%20Diagnosis%20&%20Treatment.jpeg)
Introduction
Cystic fibrosis is caused by mutations in the CFTR (cystic fibrosis transmembrane …
Contact Dermatitis: Symptoms, Causes, Types & Treatments
Contact Dermatitis: Symptoms, Causes, Types & Treatments
Contact dermatitis is a common skin condition characterized by inflammation of the skin due to exposure to certain irritants or allergens. It can cause discomfort, itching, and redness. Let’s explore the symptoms, causes, types, and available treatments for contact dermatitis.

Introduction
Contact dermatitis …
Constipation; Symptoms, Causes, Treatment & Prevention
Constipation: Symptoms, Causes, Treatment & Prevention
Introduction
Constipation is a common issue characterized by infrequent bowel movements or difficulty passing stool. It typically involves fewer than three stools per week or straining during bowel movements. Let’s explore the key aspects of constipation:

Symptoms
- Frequency: Passing fewer than three stools a …
Commotio Cordis: Causes, Symptoms & Treatment
Commotio Cordis: Causes, Symptoms & Treatment
Introduction
Commotio cordis is a rare but potentially life-threatening condition caused by a sudden impact to the chest, typically during sports or recreational activities. Let’s delve into the key aspects of commotio cordis:

Causes
- Blunt Chest Trauma:
- Commotio cordis occurs when a direct blow …
Cerebral Palsy; Symptoms, Causes, Management & Treatment
Cerebral Palsy: Symptoms, Causes, Management & Treatment
Cerebral palsy (CP) is a group of permanent movement disorders that affect muscle coordination and body movement. It primarily develops during early childhood due to brain damage or abnormal brain development. Let’s explore the key aspects of CP:

Introduction
Cerebral palsy is a …
Cauliflower Ear: What It Is, Causes & Treatment
Cauliflower Ear: What It Is, Causes & Treatment
Cauliflower ear, also known as auricular hematoma, is a condition that affects the external part of the ear. It occurs due to trauma or injury to the ear, resulting in blood accumulation between the cartilage and the perichondrium (the connective tissue covering the …
Bunions: What Causes Them, Treatment & Prevention
Bunions: What Causes Them, Treatment & Prevention
A bunion is a bony bump that forms on the joint at the base of your big toe. It occurs when some of the bones in the front part of your foot move out of place. Let’s explore the key aspects of bunions …
Blepharitis (Eyelid Inflammation): Causes & Treatment
Blepharitis: Causes and Treatment
Introduction
Blepharitis is a common eye condition characterized by inflammation of the eyelids. It affects the edges of the eyelids, where the eyelashes grow. Let’s explore the causes, symptoms, and treatment options for blepharitis.

1. What Is Blepharitis?
Blepharitis occurs when the oil glands at …
Bartholin Cyst: Causes, Treatment, Symptoms & Removal
Bartholin Cyst: Causes, Treatment, Symptoms & Removal
Introduction
A Bartholin cyst, also known as a Bartholin gland cyst, is a common condition affecting the Bartholin glands located near the vaginal opening. These glands produce lubricating fluid for the vagina. When the ducts of these glands become blocked, a cyst can form …
Autoimmune Diseases: Causes, Symptoms, What Is It & Treatment
Autoimmune Diseases: Causes, Symptoms, and Treatment
Introduction
Autoimmune diseases are a group of complex disorders where the immune system mistakenly attacks healthy cells and tissues within the body. These conditions can affect various organs and systems, leading to chronic inflammation and potentially severe health consequences. In this article, we’ll …
Atopic Dermatitis: What It Is, Symptoms, Causes & Treatment
Atopic Dermatitis: What It Is, Symptoms, Causes & Treatment
Introduction
Atopic dermatitis, commonly known as eczema, is a chronic skin condition that affects millions of people worldwide. It is characterized by red, itchy, and inflamed skin. Let’s explore the key aspects of atopic dermatitis:

1. What Is Atopic Dermatitis?
Atopic …
Asthma: Types, Causes, Symptoms, Diagnosis & Treatment
Asthma: Types, Causes, Symptoms, Diagnosis & Treatment
Introduction
Asthma is a chronic respiratory condition that affects millions of people worldwide. It is characterized by inflammation and narrowing of the airways, leading to symptoms such as wheezing, shortness of breath, and coughing. In this article, we’ll explore the different types of …
Asbestosis: Causes, Symptoms, Diagnosis & Treatment
Asbestosis: Causes, Symptoms, Diagnosis & Treatment
Introduction
Asbestosis is a chronic lung disease caused by inhaling asbestos fibers. These tiny fibers can become lodged within the alveoli (tiny sacs inside the lungs), leading to lung tissue scarring and shortness of breath. Although symptoms may not appear until many years after initial …
Angina: Symptoms, Causes & Treatment
Status: published
Angina: Symptoms, Causes & Treatment
Introduction
Angina is a term used for chest pain caused by reduced blood flow to the heart muscles. It’s a symptom of coronary artery disease and is often described as squeezing, pressure, heaviness, or tightness in the chest. Angina is a warning sign …
Anal Fissure: What It Is, Symptoms, Causes & Treatment
Anal Fissure: What It Is, Symptoms, Causes & Treatment
Introduction
An anal fissure is a small tear in the thin, moist tissue (mucosa) lining the anus, which can be uncomfortable and cause symptoms like pain during bowel movements. Understanding this condition is key to managing and treating it effectively.

What is …
Amyotrophic Lateral Sclerosis: What Is It, Symptoms & Management
Amyotrophic Lateral Sclerosis: What Is It, Symptoms & Management
Introduction
Amyotrophic Lateral Sclerosis (ALS) is a progressive neurodegenerative disease that affects nerve cells in the brain and spinal cord, leading to loss of muscle control. Often referred to as Lou Gehrig’s disease, ALS does not have a known cure, making …
Parasites: Types, Symptoms, Treatment & Prevention
Introduction
Parasites are organisms that live on or in a host organism and get their food from or at the expense of their host. They can cause a wide range of health problems, from mild discomfort to serious illness. It's important to understand the different types of parasites, the symptoms …
Sinus Infection (Sinusitis): Causes, Symptoms & Treatment
Causes of Sinus Infections
Introduction
A sinus infection, medically known as sinusitis, is an inflammation or swelling of the tissue lining the sinuses. Sinuses are hollow air-filled cavities within the bones surrounding the nose. When these cavities become blocked and filled with fluid, germs can grow and cause an infection …
What Are 2024's Holistic Healing Trends?
Holistic Healing Trends for 2024
Introduction
As we step into 2024, holistic healing continues to gain momentum as people seek comprehensive approaches to well-being. These trends go beyond physical health, emphasizing mind-body connections, community, and sustainable practices. Let’s explore the holistic healing trends that are set to make waves …
The Best Wellness Retreats of 2024
The Best Wellness Retreats of 2024
Introduction
Wellness retreats have gained popularity as people seek holistic experiences that focus on physical, mental, and emotional well-being. Whether you’re looking to recharge, deepen your yoga practice, or simply unwind in a serene environment, the best wellness retreats of 2024 offer a …
Find Your Workout Motivation: Tips and Tricks
Find Your Workout Motivation: Tips and Tricks
Introduction
Workout motivation is like a fickle friend—it shows up some days, and other days it’s nowhere to be found. But fear not! With the right strategies, you can ignite that inner fire and stay committed to your fitness journey. Whether …
Digestive Health Tips for a Happier Gut
Digestive Health Tips for a Happier Gut
Introduction
Maintaining good digestive health is essential for overall well-being. A healthy gut not only aids in digestion but also impacts our immune system, mood, and energy levels. In this article, we’ll explore practical tips to promote a happier gut.

1. Eat …
Cold Sores: Causes, Treatment and Prevention

Although cold sores can be embarrassing, they are extremely common. Many people have had at least one at some point. Cold sores are caused by the herpes simplex virus type 1 (HSV-1), which is very contagious. In the United States, nearly half of Americans between the …
Genital Warts: Causes, Symptoms, Treatment & Prevention

Most sexually active people will eventually contract the human papillomavirus (HPV), with up to 90% of men and 80% of women impacted by this virus at least once. Of the vast strains of HPV that exist, some types cause a condition known as genital warts. These …
Hives: Causes, Symptoms, Diagnosis, Treatment & Prevention

If you’ve ever had a red, itchy bump on your skin that went away as quickly as it appeared, you may have had hives. About 20% of the general population will have hives at some point. Since they disappear on their own for most people …
Type 2 Diabetes: What Is It, Causes, Symptoms, Risk Factors & Treatments

Type 2 diabetes is a condition that affects 462 million people worldwide, making it not only the most common type of diabetes but also one of the most common health conditions. If you have type 2 diabetes, your body can’t process sugars (glucose) from food …
Food Poisoning (Foodborne Illness): Symptoms, Signs, and Treatment

Everyone has woken up at some point with an upset stomach or diarrhea and wondered: is it something I ate? Food poisoning is incredibly common, with approximately one in six Americans experiencing symptoms of this condition each year.
Fortunately, many cases of food poisoning are considered …
Early Signs of Alzheimer's and How to Take a Self-Assessment

Everyone forgets things from time to time. But when someone frequently forgets names, struggles to follow a conversation or repeats themselves, or begins to misplace objects regularly, these can be warning signs of early Alzheimer's.
Take note of any new symptoms you or a loved one …
Myeloma - Early Signs and Treatment Options
Myeloma can cause high calcium levels in the blood, kidney failure and anemia. It can also cause damage to the bones of the spine and ribs.
Plasma cells (B lymphocytes) are made in your bone marrow and are part of your immune system. They help fight infection by making proteins …
O VIH é curável? O que você precisa saber sobre esta condição

"Nas últimas quatro décadas, o HIV tem sido um grande problema global de saúde pública. Em todo o mundo, mais de 40 milhões de pessoas morreram da doença. Desde então, os cientistas têm trabalhado para desenvolver tratamentos eficazes, vacinas e uma cura. Até agora, só existe …
¿Es curable el VIH? Lo que necesita saber sobre esta afección

Durante las últimas cuatro décadas, el VIH ha sido un importante problema de salud pública a nivel mundial. En todo el mundo, más de 40 millones de personas han muerto a causa de esta enfermedad. Desde entonces, los científicos han trabajado en tratamientos, vacunas y una …
Lo que debes saber sobre la disfunción eréctil

La disfunción eréctil (DE) afecta a unos 30 millones de hombres en Estados Unidos. La DE es una condición en la que no puedes conseguir o mantener una erección lo suficientemente firme para tener relaciones sexuales. Aunque tener problemas ocasionales de erección no es motivo de …
Señales para identificar el trastorno bipolar y cómo manejarlo

Una persona con trastorno bipolar puede experimentar altibajos emocionales extremos. Estos cambios de humor pueden causar problemas en el hogar, el trabajo y la escuela. Anima a tus seres queridos a buscar ayuda de un terapeuta y recibir tratamiento si están experimentando episodios de depresión o …
O que você deve saber sobre disfunção erétil

A disfunção erétil (DE) afeta cerca de 30 milhões de homens nos Estados Unidos. A DE é uma condição em que você não consegue obter ou manter uma ereção firme o suficiente para o sexo. Embora problemas ocasionais de ereção não sejam motivo de preocupação, se …
Surprising Early Signs of HIV (Everyone Needs to Know)

In the early (acute) stage of HIV infection, your immune system is fighting the virus. This fight can lead to a wide range of symptoms.
These symptoms can involve the gastrointestinal tract, the central nervous system or other organs such as the eyes, lungs and kidneys …
COPD: Treatment & Signs

Often, it takes years for people to notice symptoms of COPD. It is not normal to cough up phlegm regularly or feel breathless.
Your doctor will listen to your lungs with a stethoscope and order lung function tests. These usually include spirometry. You will blow air …
Aphasia: Types, Causes, Symptoms & Treatment

In the United States, there are at least two million people with aphasia. Despite the prevalence of the condition, it’s relatively unknown to the majority of the American population. Aphasia is a disorder where you have trouble speaking or understanding others because of damage to …
Astigmatism: Symptoms, Tests & Treatment

If you’ve dealt with distorted or blurry vision, you know how problematic it can be when your eyes aren’t working correctly. It can make tasks like driving or looking at a computer difficult. While different conditions can cause blurry vision, astigmatism's defining symptom is …
Depression: Causes, Symptoms, Types & Treatment

Depression is a common mental health issue that can cause feelings of hopelessness, helplessness, and worthlessness. If you’re dealing with depression, it may be hard to focus on your daily activities, maintain relationships with others, and feel good about yourself.
Depression can cause suicidal thoughts …
Vertigo: Symptoms, Causes & Treatment

Vertigo and dizziness are among the most common reasons for seeking medical care; these symptoms account for 2% to 3% of all consultations in emergency departments. Women are slightly more likely to have vertigo, a condition that causes someone to feel like they’re spinning or …
Sleep Apnea: What It Is, Causes, Symptoms & Treatment

If you’re feeling fatigued throughout the day, no matter how much sleep you get, you could have a sleep disorder such as sleep apnea. Sleep apnea occurs when you stop breathing while sleeping. You can stop breathing many times throughout the night.
Some people don …
Preeclampsia: Symptoms, Causes, Treatments & Prevention

For many women, the first trimester of pregnancy is the hardest. Those first few months can bring symptoms such as morning sickness, loss of appetite, and sleep deprivation. While the second trimester tends to be easier for expectant mothers, it’s also when preeclampsia tends to …
Gout: Symptoms, Treatment & Prevention

There are over 100 different variations of arthritis, yet one common form is known as gout. Gout is caused by a build-up of uric acid (urate) in the body. Urid acid is produced when the body breaks down purines, which are found in foods like bacon …
Sepsis: Symptoms, Causes, Treatment & Prevention

Sepsis is a serious reaction your body has to an infection, and it’s a condition that at least 1.7 million adults in America develop each year. When you have an infection, your immune system jumps into action to stop it. But in some cases …
Staph Infection: Causes, Symptoms, Diagnosis & Treatment

We know there are both good and bad bacteria, but did you know a quarter of people carry a type of bacteria called staphylococcus and aren’t aware of it? Staphylococcus, or staph for short, is a type of bacteria that 25% of people carry in …
Skin Lesions: What They Are, Types, Causes & Treatment

A skin lesion is a part of your skin that looks or feels abnormal compared to the skin around it. They are common conditions and can be as simple as a result of an injury or damage to your skin, like a sunburn, or they can …
Ectopic Pregnancy: Causes, Symptoms & Treatments

Ectopic pregnancy occurs when an egg is fertilized outside the uterus. For most people, ectopic pregnancy happens when egg fertilization occurs in the fallopian tubes, not the uterus. Ectopic pregnancy can be very damaging to the individual and can cause harm to your internal organs.
Treatments …
Ulcerative Colitis: Symptoms, Treatment & Living With It & Diagnosis

In the United States, 600,000 to 900,000 people live with ulcerative colitis (UC). Ulcerative colitis is a chronic illness that causes irritation and open sores in the lining of the large intestine. This disease belongs to a group of conditions called irritable bowel disease …
Bacterial Vaginosis (BV): Causes, Symptoms & Treatment

Bacterial vaginosis is a common condition that occurs when natural bacteria in your vagina become unbalanced. Some people may experience uncomfortable symptoms with bacterial vaginosis, such as itching and abnormal discharge, while others may experience no symptoms at all.
There are several treatment options available for …
Lymphoma: Signs & Symptoms, Causes, Diagnosis & Treatment

Cancer of the lymphatic system is known as Lymphoma. A cancer diagnosis can be overwhelming and anxiety-provoking. There are two types of Lymphoma: non-Hodgkin Lymphoma and Hodgkin Lymphoma.
The prognosis of Lymphoma is different for each individual. There are available treatment options. If you notice symptoms …
Whiplash (Neck Strain): What It Is, Symptoms & Treatment

Whiplash, also called neck sprain or neck strain, is an injury that occurs due to forceful, back-and-forth movement of the neck. It often affects the neck's discs, muscles, nerves, and tendons.
Most whiplash injuries are the result of a collision that involves sudden acceleration or deceleration …
Keratosis Pilaris: What It Is, Causes, Symptoms & Treatment

Keratosis pilaris is a common condition where small, rough bumps form on the skin. They may look like goosebumps, which often occur as a result of emotions—such as fear—or extreme temperatures, but they can also be mistaken for small pimples. It can also resemble …
Irritable Bowel Syndrome: IBS, Symptoms, Causes, & Treatment

Irritable bowel syndrome is a common condition that affects your bowels and can cause numerous unpleasant symptoms. If you eat food only to rush to the bathroom shortly after because your bowels are upset, you might have Irritable Bowel Syndrome (IBS).
The key features of IBS …
Hidden Symptoms & Signs of HIV

HIV assaults immune system cells, destroying them and leaving the body vulnerable to infection. If not treated promptly, the virus can progress to AIDS.
A person with AIDS may have a variety of symptoms, including flu-like symptoms and a rash. Some people may also have a …
Stye (Sty): What Is It, Causes, Treatment & Prevention

A stye is a red bump on the edge of your eyelid that is painful and looks somewhat similar to an acne pimple. It forms when an oil-producing gland in your eyelid or eyelash follicle gets blocked, attracting bacteria that cause an infection. Styes are very …
Canker Sore (Aphthous Ulcer): What It Is, Causes & Treatment

Around 1 in 10 people have canker sores from time to time. These shallow sores appear in the lining of your mouth. While they’re not contagious, they can be irritating and even painful. Canker sores start as white or yellowish with a red border. They …
Chlamydia: Causes, Symptoms, Treatment & Prevention

If you’re sexually active, you are at risk for sexually transmitted infections (STIs). STIs can cause various symptoms that can cause discomfort and be unpleasant to deal with. One sexually transmitted infection is chlamydia, which can cause detrimental reproductive effects in women.
If you have …
Trypophobia: What Is It, Triggers, Symptoms, Diagnosis & Treatment

Trypophobia (which comes from the Greek words trypos for "holes" and phobos for "fear") is a fear response that is activated by viewing holes, specifically in an irregular pattern or cluster. This condition is incredibly common, with an estimated one in six individuals experiencing a degree …
Hemorrhoids Treatment, Symptoms, Causes & Prevention

Hemorrhoids are veins around your anus and inside of your rectum. Everyone has these veins, and they usually don’t cause any problems. But when the veins swell or become inflamed, they can cause pain, rectal bleeding, and itching. This condition, simply known as “hemorrhoids,” affects …
Celiac Disease: Symptoms & How It’s Treated

Celiac disease is an autoimmune condition that causes ingested gluten to damage the small intestine. Around the world, approximately one in 100 people have celiac disease, but most have not been diagnosed with it. If you have celiac disease, eating gluten — a protein in barley, rye, and …
How to Manage Eosinophilic Asthma

Eosinophils are part of your immune system and help protect you from infection. However, if they are too high, they can trigger inflammatory reactions that cause asthma symptoms.
Doctors used to think of asthma as one disease, but they now realize that there are many different …
Crohn’s Disease: Symptoms, Causes, Management & Treatment

Crohn's disease is a condition that leads to chronic inflammation of the small intestine, large intestine, and/or colon. This disease impacts the health of the digestive tract, leading to symptoms such as diarrhea, abdominal pain, and weight loss. Over time, Crohn's can take a toll …
Pink Eye (Conjunctivitis): Causes, Treatment & Prevention

In the United States, pink eye (conjunctivitis) affects an average of 6 million people every year. Pink eye is an eye infection that results in inflammation in the tissues that line your eyelids (the conjunctiva). Different types of pink eye, including bacterial, viral, and allergic conjunctivitis …
Shingles (Herpes Zoster): Symptoms & Treatment

In the United States, an average of 1 million people get shingles every year. If you’ve ever had chickenpox, there’s a good chance you’ll get shingles. This viral condition causes a rash and blisters on the skin, often in bands along one side …
Pneumonia: Causes, Symptoms, Diagnosis & Treatment

Pneumonia is one of the most common respiratory diseases, affecting millions worldwide each year. Although pneumonia generally falls into three broad categories, there are more than 30 causes of the disease. Identifying the cause of pneumonia is especially important for getting the proper treatment.
What Is …
Hernia: What It Is, Symptoms, Types, Causes & Treatment

Healthcare providers worldwide repair more than 20 million hernias each year, but many more go undiagnosed and untreated. A hernia is when an organ pushes through the tissue or muscle that contains it. The most common types of hernias occur in the abdominal area. Many hernias …
Tonsil Stones (Tonsillolith): Causes, Symptoms, Removal & Treatment

Tonsil stones (tonsillolith) are one of the body's most unique defense systems: by isolating infections into these stones, bacteria stuck in the tonsils can't migrate through the body. Tonsil stones are largely compromised of minerals (calcium) and are often visible to the naked eye, though few …
6 Foods That Help Manage Seizures

About 3.4 million Americans live with epilepsy, which is a central nervous system disorder that causes seizures. But many people can manage their symptoms with anti-seizure medication.
In addition to prescription medications, a diet may also help reduce the frequency and severity of seizures. A …
Diabetes Management: How to Reduce A1C Levels

If you have diabetes, there are certain habits that you should be in to lower your A1C levels. These include adjusting your diet, getting enough exercise and taking your medications as directed.
Carbohydrates get a bad reputation, but it is important to consume them in small …
How to Fix Hormonal Imbalances Naturally

Hormones are chemical messengers that send critical messages through the body, helping to regulate everything from appetite and metabolism to menstrual cycles and sexual function. When hormones are out of balance, you may experience symptoms like fatigue or weight gain.
Conventional doctors often offer Band-Aid solutions …
5 Secret Signs of High Blood Sugar

People with diabetes must test their blood sugar levels often to stay within a target range. When their levels get high, it's called hyperglycemia.
Symptoms of high blood sugar include classic signs like frequent urination, excessive thirst, and unexplained weight loss. But some of the symptoms …
AFIB Symptoms and Treatment

AFib can raise your odds of stroke, heart failure and dementia. It can also make breathing difficult.
A health care provider will do a physical exam and ask you about your symptoms. They might use an EKG to check your heart rhythm.
AFib can come and …
Signs and Symptoms of Huntington's Disease

Symptoms of HD appear between ages 30 and 50 but can be as early as age 2. These symptoms include unwanted choreatic movements, decline in thinking skills, psychiatric changes, and other symptoms.
Genetic testing can be done to see if you have inherited the …
Pancreatitis: Symptoms, Causes & Treatment

The large gland behind your stomach is called your pancreas. The pancreas has two essential functions; the first is to make insulin, and the second is to make juices that
help you digest your food. When the pancreas becomes inflamed, you may develop
a condition called …
Chickenpox: Causes, Symptoms, Treatment & Prevention

Before the introduction of a vaccine in 1995, almost every American child caught a case of chickenpox. Since most people develop immunity after one round of infection, parents would even group together their healthy children and sick children to expose them to the illness in one …
Warning Signs & Treatment Options For Parkinsons

Many symptoms that don't involve movement can be a warning sign for Parkinson's. They may start years or even decades before motor symptoms.
Some non-motor signs include a mask-like facial expression, drooling and cramped handwriting. Others are less obvious, such as a change in your sense …
Kidney Stones: Symptoms, Causes, Diagnosis, Treatment & Prevention

Anyone who has experienced a kidney stone understands the frustration of waiting for it to pass. Kidney stones are solid deposits that form when crystalizing substances in the urine are too high or are not properly absorbed by the kidneys. These stones don't always have symptoms …
Spider Bites: Signs, Symptoms, Diagnosis, Treatment & Prevention

With eight legs and bulbous eyes, spiders may look spooky, yet they are far more passive than pop culture would lead you to believe. Spiders primarily eat insects, so humans are low on their list to attack. However, if you cross into a spider's space or …
Fibromyalgia: Symptoms, Diagnosis & Treatment

Fibromyalgia is a chronic condition that causes widespread pain throughout the musculoskeletal system, including the muscles and joints. It isn't easy to identify, as diagnosis often requires eliminating similar conditions. On average, it takes patients five years to receive a fibromyalgia diagnosis from the time they …
Anemia: Causes, Symptoms & Treatment

Anemia is the most common blood disorder in the United States, affecting more than 3 million Americans and nearly 3 billion people worldwide in 2021. While anemia is preventable and treatable, it can cause serious health issues in more severe cases.
What Is Anemia?
Anemia occurs …
Diabetic Macular Edema: How to Diagnose This Condition

Diabetes affects the tiny blood vessels in the eye, which can leak fluid into the central retina (the part of the eye that provides sharp vision). This can lead to macular edema.
Diabetic macular edema is a serious complication of diabetes that can cause vision loss …
What You Need to Know About Vitiligo

Although vitiligo isn’t dangerous, it's important to seek treatment to slow the progression of discoloration and help restore a more normal appearance.
Your doctor will examine your skin and ask you about any other symptoms you’ve had. He or she may also order blood …
Scalp Psoriasis: Causes, Symptoms & Treatments

Psoriasis can occur anywhere on the skin, including the scalp. It can look like dandruff, with plaques of thick white or silvery scales. It may also affect the hairline, forehead and ears.
Topical medications, oral medicines and phototherapy can help improve your condition. Your doctor can …
How to Treat Hidradenitis Suppurativa

A dermatologist can create a treatment plan to relieve symptoms and prevent further damage. Treatment may include surgically removing the areas that are most prone to painful boils.
HS is a chronic condition, and people with HS often have periods of improvement or worsening. There's no …
Is HIV curable? What You Need to Know About This Condition

For the past four decades, HIV has been a major global public health issue. Worldwide, more than 40 million people have died from the disease. Since then, scientists have worked toward effective treatments, vaccines, and a cure. So far, there has only been one effective treatment …
Lyme Disease: Symptoms, Treatment, Prevention & Recovery

If you are outside often, especially in areas with lots of ticks, it’s helpful to be aware of tick-borne illnesses. Illnesses from ticks can cause many symptoms that can be severe when left untreated. One common tick-borne illness is Lyme disease, caused by bacteria that …
Insomnia: What It Is, Causes, Symptoms & Treatment

Getting quality sleep is helpful to your mental and physical well-being. There are various benefits of sleeping well. Difficulty falling asleep or staying asleep at night may indicate a sleep disorder.
Insomnia occurs when you have trouble falling asleep, which causes you to stay up most …
What Happens If You Get Hepatitis?

The liver plays an essential role in filtering toxins out of our bodies, storing vitamins and hormones, and performing other important tasks. Viral hepatitis -- caused by infections with viruses such as A, B and C -- can inflame liver tissue leading to permanent damage and even cirrhosis …
Best Treatments For Dry Eyes

Most people with dry eye have a chronic condition that requires long-term treatment. New therapies can now help with the symptoms and underlying cause of the disease.
These include a new drug that increases tear production, and a thermal pulsation therapy that opens up the oil …
The Benefits of Physical Therapy for Parkinson's Disease

When a person with Parkinson’s disease starts losing movement, the impact can be devastating. However, new research shows that exercise can help slow the progression of symptoms.
A physical therapist can help develop an exercise program that will improve your mobility and quality of life …
The Best Vitamins and Remedies For Sinusitis

Keeping your sinuses healthy can help prevent infections and chronic sinus congestion. Diet, saline nasal sprays and herbal supplements can all play an important role.
N-acetylcysteine is an amino acid derivative with mucolytic properties that may help thin the mucus in your sinuses, allowing it to …
Dermatitis 101: What Are the First Signs of Dermatitis?

Dermatitis can develop on any area of the body and at any age. It often starts in early childhood. Rashes may ooze clear fluid or bleed. The itching is intense. Scratching can make the rash worse.
A rash called atopic dermatitis is the most common type …
Adult Onset Spinal Muscular Atrophy: A Guide to This Condition

A diagnosis of SMA can have a profound impact on your life. You will need long term multidisciplinary healthcare and support to maintain your independence and quality of life.
Most kinds of SMA are caused by changes (mutations) in the gene called SMN1. This gene makes …
Signs and Symptoms of Angioedema

Often, when an allergic reaction causes angioedema, it also produces hives. These itchy welts may appear on any part of your body, but they are most common on the hands and feet, the back of the throat, lips, mouth or tongue, and genitals.
Sometimes a person …
5 Common Signs Of A Weak Immune System

Your immune system is a collection of organs, cells and proteins that defends your body from germs. It protects you from colds, infections and even serious illnesses.
If you’re constantly popping antibiotics or visiting your doctor to curb illness that keeps resurfacing then it could …
Lung Cancer: Types and Early Signs of This Condition

Cancer can start in many places in the body. Sometimes it spreads to the lungs from other parts of the body.
When you breathe in, air goes into your lungs through your windpipe (trachea). Your lungs are lined with tubes called bronchi. These bronchi branch into …
4 Serious Warning Signs Of Poor Blood Circulation

Poor blood circulation can lead to serious health problems such as blood clots and infected skin ulcers. That’s why it’s essential to report any symptom of poor circulation to a doctor right away.
A common warning sign is cold feet and hands, but it …
Appendicitis: Signs & Symptoms, Causes, Diagnosis & Treatment

If you've been experiencing pain in your lower right abdomen accompanied by fever or nausea, you could have appendicitis. Appendicitis is dangerous because it can rupture and cause sepsis if left untreated. Knowing the signs and symptoms of appendicitis can help you assess whether you or …
A Quick Guide to ABA Programs For Children With Autism

ABA programs usually involve up to 40 hours of one-on-one therapy with certified therapists. The therapists will teach your child to reinforce useful behaviors while discouraging unhelpful ones. They also encourage caregivers and other family members to practice the same techniques with their children.
Some parents …
Symptoms of Tinnitus That May Surprise You

A ringing in your ears is the most common symptom of tinnitus. Other sounds include clicking, roaring, hissing and buzzing.
A health problem such as a jaw joint problem or clenching, ear infections, head and neck injuries, high blood pressure, diabetes or tumors may cause the …
5 of the Most Common Early Dementia Symptoms

The most common early dementia symptoms are problems with memory. For example, a person might forget where they are or have trouble following a recipe or paying bills.
They may also put things in strange places or lose them and have difficulty retracing steps. This can …
Impetigo, Contagious Skin Infection: Causes, Treatment & Prevention

Impetigo is a highly infectious skin condition that causes blistering sores on the affected skin. While the condition is generally short-lived, it can cause pain, itching, and general discomfort for its lifespan. Impetigo often impacts children and infants who frequently exchange bacteria in daycares, schools, and …
How Do I Reduce Sciatica Nerve Pain?

If you’ve ever had a sudden sharp pain in your lower back or hip that went down into your leg, you may have experienced sciatica nerve pain. Between 10% to 40% of the population experience sciatica during their lifetime. Sciatica before the age of 20 …
Cellulitis: Symptoms, Causes, Treatment & Recovery

Cellulitis is a bacterial infection that impacts the deeper layers of tissue in the skin. This condition often springs up in the legs and feet, creating inflamed, reddened areas that are painful or hot to the touch. An estimated 14 million Americans are diagnosed with cellulitis …
The Best Treatment Options for Psoriasis

Approximately 7.5 million people in the United States have psoriasis. Psoriasis is an autoimmune condition that affects your skin, causing inflammation, discomfort, and itchiness. People with psoriasis have patches of thick, scaly skin called plaques, usually on the knees, elbows, scalp, and trunk. It is …
Lupus: Symptoms, Causes, Types & Treatments

Lupus is an autoimmune condition that affects multiple parts of the body. Lupus is a complex condition to pinpoint due to its symptoms mimicking those of other diseases. Further complicating the matter, the symptoms are often unique to each individual. Individuals with lupus may experience symptoms …
Adult Onset Spinal Muscular Atrophy: Diagnosis, Symptoms and Treatment

A diagnosis of Adult Onset Spinal Muscular Atrophy (SMA) can have a profound impact on your life. You may need long term multidisciplinary healthcare and support to maintain your independence and quality of life.
Most kinds of SMA are caused by changes (mutations) in the gene …
How to Recognize the Symptoms of Eczema

An estimated 30% of the U.S. population has some form of eczema. It’s a condition that affects people of all ages, genders, and ethnicities and can flare up when you least expect it. Eczema, or atopic dermatitis, is an inflammatory condition that can cause …
Strep Throat: Symptoms, Causes, Diagnosis & Treatment

The discomfort caused by strep throat is something that most people don’t easily forget. While viral infections cause most sore throats, strep throat results from a bacteria called group A Streptococcus. That’s why treating it requires more than just teas and over-the-counter painkillers. This …
Signs and Symptoms of Angioedema

Often, when an allergic reaction causes angioedema, it also produces hives. These itchy welts may appear on any part of your body, but they are most common on the hands and feet, the back of the throat, lips, mouth or tongue, and genitals.
Sometimes a person …
What Are the Best Ways to Relieve Hip Pain?

The hip is one of the most important joints in the body. It plays a critical role in mobility and stability, enabling us to perform daily activities such as walking, jumping, or lifting. So it’s no surprise that hip pain can sideline us if we …
What Is Lymphoma?

If you or a loved one have been diagnosed with lymphoma, you probably have a lot of questions and concerns. Getting any diagnosis can be overwhelming, especially if a doctor says you have cancer. It may feel like your entire life has been turned upside down …
What Are the First Signs of Kidney Disease?

The role of the kidneys is to filter toxins from the blood and create urine, releasing waste from your body. Kidney disease occurs when your kidneys can't function sufficiently, causing waste to build up in the blood and damage your organs.
This …
How to Treat Wet AMD

In the United States, about 19.8 million people live with age-related macular degeneration (AMD). Although the majority of people have the dry, less severe form of AMD, some people develop the wet type, which can affect their vision. Wet age-related macular degeneration is a long-lasting …
What causes OCD?

Like many mental health conditions, obsessive-compulsive disorder (OCD) is often misunderstood. TV shows portray people with OCD as “quirky,” rigid, and inflexible. People who call themselves “neat freaks” may claim to have OCD. Cleanliness is one aspect of OCD, but it is much more complicated than …
What Causes Multiple Sclerosis?

Multiple sclerosis (MS) is a progressive autoimmune disease resulting from damaged nerve sheaths in the brain and spine. While this disease is known for the muscle weakness that it causes over time, MS initially has the same symptoms as many other common illnesses, making it difficult …
How to Treat Atopic Dermatitis

In the United States alone, 16.5 million people have atopic dermatitis, with many living with moderate to severe symptoms. In the past, atopic dermatitis was considered to be a condition that only affected children, characterized by symptoms starting before the teen years and then gradually …
What causes colon cancer?

If you have recently been diagnosed with colorectal cancer or know someone who has been diagnosed, you probably have a lot of questions. The good news is that colorectal cancer is highly treatable—and often curable—in the early stages. Regular screenings can usually find cancer …
What Causes Heart Disease?

Heart disease (also known as cardiovascular disease or CVD) is a term used to describe a range of damaging heart conditions. It's the leading cause of death in the United States, with nearly 700,000 passing from heart disease yearly.
Although heart disease statistics are nerve-wracking …
What are the symptoms of asthma?

If you sometimes have trouble breathing, you might wonder if you have asthma. If so, you’re not alone. Asthma is one of the most common diseases in the United States. Nearly 26 million people have it—that’s 1 in 13 people. It affects people …
What You Should Know About Erectile Dysfunction

Erectile dysfunction (ED) affects about 30 million men in America. ED is a condition in which you cannot get or maintain an erection firm enough for sexual intercourse. Though occasional erection problems are not a cause for concern, if the problem persists, it can cause stress …
What Are Symptoms of Breast Cancer?

Breast cancer is more common than any other cancer, with a new case diagnosed every two minutes in the United States. While breast cancer is classified as either invasive or non-invasive, there are many different types of breast cancer, making early screening all the more important …
How to Treat Macular Degeneration

In 2019, more than 10% of Americans over the age of forty were living with some form of macular degeneration. This condition is primarily an age-related retinal problem that can lead to the loss of central vision. Loss of this sort makes it difficult to see …
What are signs of prostate cancer?

Of every 100 American men, an average of 13 will get prostate cancer during their lifetimes. Although prostate cancer is a serious condition, men who get treatment early have a high chance of recovery.
Learning to recognize the signs of prostate cancer and knowing the risk …
What Are the Causes of Rheumatoid Arthritis?

In the United States, 1.5 million people live with rheumatoid arthritis. RA is an inflammatory and autoimmune condition in which your body’s immune system damages healthy cells by mistake, considering them foreign invaders like viruses or bacteria. This disease is a systemic one, meaning …
What is Crohn's Disease? Symptoms, Diagnosis & Treatment

In the United States, over half a million people live with Crohn’s disease, an inflammatory bowel disease (IBD). This chronic condition, which is also known as ileitis or regional enteritis, causes inflammation and irritation in the digestive tract. Crohn’s disease can be debilitating and …
What Are The Symptoms of ADHD?

Attention-deficit/hyperactivity disorder (ADHD) is a condition that affects children, teens, and adults. In the United States, 4% of adults live with this developmental condition that can impact their relationships, careers, and overall quality of life.
Most people have an idea of what ADHD looks like …
How to Test for Bipolar 1 and 2

Millions of Americans suffer from bipolar disorder, an illness characterized by extreme highs and lows. If you suspect that you may have it, try keeping a journal of your moods before consulting a mental health provider for further evaluation.
Bipolar disorder can be diagnosed when at …
What Is the Most Common Dermatitis Treatment?

For best results in treating irritant contact dermatitis, avoid all substances which exacerbate symptoms and consult your GP or dermatologist regarding patch testing to identify allergens.
Hydrate regularly using non-scented lotion or ointment. Take an anti-itch drug like hydrocortisone cream or diphenhydramine (Benadryl). Trim fingernails regularly …
What Is the Most Common Psoriatic Arthritis Treatment?

Psoriatic arthritis does not have a definitive cure; however, treatments can help relieve symptoms and slow its progress. Your doctor can advise which medicines may best serve you while also offering advice about self-care measures such as exercising with rest periods, heat or cold therapy and …
Signs Of Breast Cancer, Causes & Treatment Options

Drug therapies and surgery are the two primary options for breast cancer treatments, with your doctors (surgeon, medical oncologist and radiation oncologist) tailoring an individual treatment plan to the tumor size, location and personal circumstances.
Some women with early breast cancer opt for neoadjuvant therapy before …
How Does Plaque Psoriasis Treatment Work?

Plaque psoriasis affects more than 8 million Americans. These raised, scaly patches appear on either the skin or scalp and may cause pain and itching.
Treatment can help alleviate symptoms. Doctors usually suggest medications applied directly to your skin or scalp, like creams and ointments; these …
What Causes High Cholesterol?

High cholesterol is a condition where cholesterol, a fatty substance in our blood, reaches unhealthy levels. There are two different types of cholesterol: low-density lipoproteins (LDLs) and high-density lipoproteins (HDL). LDL, the troublesome form of cholesterol, carries cholesterol throughout the body, resulting in unhealthy cholesterol levels …
How to Deal With Depression?

Depression saps both energy and hope from you, making even basic tasks such as rising from bed or brushing your teeth feel impossible.
Stay in contact with friends and family via video calls, phone calls or texts; prioritize face-to-face interactions whenever possible.
Be mindful when speaking …
What Causes Type 2 Diabetes?

Type 2 diabetes is the most common form of diabetes. The condition occurs when cells become insulin-resistant, or the body fails to produce enough insulin. Though many adults go without a diagnosis for years, distressing symptoms of type two diabetes may emerge over time. If untreated …
What Are the Symptoms of Ulcerative Colitis?

Millions of people worldwide live with ulcerative colitis, a chronic inflammatory bowel disease (IBD). A chronic disease usually lasts three months or longer and may worsen over time. It can be scary to get a chronic disease diagnosis like ulcerative colitis. The symptoms can significantly impact …
How Do You Get Pink Eye?

Pink eye is an infection of the tissues that line the eyelid, which doctors call the conjunctiva. For this reason, the medical term for pink eye is “conjunctivitis.” You can get pink eye from bacteria, allergens, or viruses. The condition is uncomfortable, causing itching, swelling, and …
What are the Symptoms of Dehydration?

Dehydration is a serious health risk that occurs when your body loses more fluid over time than you drink. Dehydration can disrupt the balance of minerals present in your blood. It's important to be able to spot the symptoms of dehydration in yourself and those around …
Does Insurance Cover ED Treatments For Men?

If you are living with erectile dysfunction (ED), your insurance might cover medication that can help restore and sustain an erection. Thankfully, there are affordable medications which work just as effectively as the Viagra brand medication - check with your provider or pharmacy.
Medicare and most commercial …
Do Eye Injections Work For Macular Degeneration?

Eye injections are an efficient, safe, and non-invasive way of slowing or halting vision loss caused by many retinal conditions. Injections contain medication designed to stop abnormal blood vessel growth, bleeding, or fluid leakage in the retina.
What is Ant-VEGF?
Ant-VEGF therapy …
What are the Symptoms of Tardive Dyskinesia?

Tardive dyskinesia (TD) symptoms include involuntary movements like twitching and grimacing that can become extremely bothersome and severely restrict one's daily life. These discomforting movements may even pose physical threats.
This condition can cause great emotional discomfort and impact one's social life, yet natural therapies may …